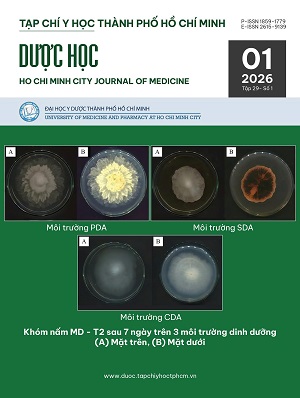

Website VJOL hiện do Cục Thông tin, Thống kê (Bộ Khoa học và Công nghệ) quản lý, duy trì và phát triển nhằm tăng cường sự hiện diện và tầm ảnh hưởng của các tạp chí khoa học Việt Nam đối với bạn đọc trong nước và quốc tế, đồng thời đẩy mạnh quá trình chuyển đổi số của các tạp chí khoa học thông qua nền tảng VJOL.
Việc đăng ký tham gia vào website VJOL là hoàn toàn miễn phí. Thông tin chi tiết mời xem phần GIỚI THIỆU.
DANH MỤC TẠP CHÍ THAM GIA:
Hiện có 385 tạp chí khoa học Việt Nam đăng ký tham gia, đăng tải dữ liệu toàn văn dưới định dạng PDF trên website VJOL.
DANH MỤC TẠP CHÍ KHOA HỌC VIỆT NAM
Gồm hơn 385 tạp chí khoa học của Việt Nam, nằm ở phần bên phải của mục “Tạp chí trên VJOL”. Để xem thông tin chi tiết của các tạp chí, vui lòng đăng nhập tên người dùng và mật khẩu theo hướng dẫn.
(Tìm kiếm nhanh tên tạp chí: bấm tổ hợp phím "Ctrl + F", sau đó đánh tên tạp chí hoặc từ khóa có trong tên của tạp chí đó)
Tạp chí
-
Tạp chí Tài chính doanh nghiệp
Tạp chí của Hội Tư vấn thuế Việt Nam
-
Tạp chí Y Dược Đại học Y khoa Vinh
Tạp chí của Trường Đại học Y khoa Vinh
-
Tạp chí Khoa học công nghệ Xây dựng
Tạp chí của Viện Khoa học công nghệ Xây dựng
-
Tạp chí Khoa học & Công nghệ - Trường Đại học Công nghiệp Hà Nội
Tạp chí của Trường Đại học Công nghiệp Hà Nội
-
Tạp chí Khoa học và Công nghệ Trường Đại học Công nghiệp Hà Nội (Bản điện tử)
Tạp chí của Trường Đại học Công nghiệp Hà Nội
-
Hanoi university of industry journal of science and technology
Tạp chí của Hanoi University of Industry
-
Journal of Science on Natural Resources and Environment
Tạp chí của Trường Đại học Tài nguyên và Môi trường Hà Nội
-
Can Tho Journal of Medicine and Pharmacy
Tạp chí của Trường Đại học Y Dược Cần Thơ
-
Tạp chí khoa học Trường Đại học Nghệ An
Tạp chí của Ủy ban nhân dân tỉnh Nghệ An
-
Tạp chí Khoa học và Công nghệ Y Dược
Tạp chí của Trường Đại học Y - Dược, Đại học Thái Nguyên.
-
Journal of Science and Technology in Medicine and Pharmacy
Tạp chí của Trường Đại học Y - Dược, Đại học Thái Nguyên
-
Tạp chí Công nghiệp quốc phòng và Kinh tế
Tổng cục Công nghiệp quốc phòng, Bộ Quốc phòng.
-
Tạp chí Quan hệ Quốc phòng
Tạp chí của Viện Quan hệ Quốc tế về Quốc phòng
-
Tạp chí Quốc phòng toàn dân
Tạp chí Quân ủy Trung ương và Bộ Quốc phòng
-
Tạp chí Văn hóa, Thể thao và Du lịch - khoa học thể thao
Tạp chí của Viện Văn hóa, Nghệ thuật, Thể thao và Du lịch Việt Nam
-
Tạp chí Văn hóa, Thể thao và Du lịch - Văn hoá học
Tạp chí của Viện Văn hóa, Nghệ thuật, Thể thao và Du lịch Việt Nam
-
Tạp chí Cộng sản - Xây dựng Đảng
Tạp chí của Ban Chấp hành Trung ương Đảng
-
Tạp chí Cộng sản - chuyên đề
Tạp chí của Ban Chấp hành Trung ương Đảng
-
Tạp chí Khoa học Trường Đại học Tân Tạo
Tạp chí của Trường Đại học Tân Tạo
-
Tạp chí Lịch sử Đảng (Điện tử)
Tạp chí của Viện Lịch sử Đảng - Học viện Chính trị quốc gia Hồ Chí Minh
-
Tạp chí OmonRice
Tạp chí của Viện Lúa Đồng bằng sông Cửu Long - Viện Khoa Học Nông Nghiệp Việt Nam
-
Tạp chí Khoa học Tiêu hóa Việt Nam
Tạp chí của Hội Khoa học Tiêu hóa Việt Nam
-
Tạp chí Y học Thành phố Hồ Chí Minh – Dược học
Tạp chí của Đại học Y Dược TP. Hồ Chí Minh
-
Hong Bang International University Journal of Science
Tạp chí của Trường đại học Quốc tế Hồng Bàng
-
Tạp chí Khoa học Trường Đại học Quốc tế Hồng Bàng
Tạp chí của Trường đại học Quốc tế Hồng Bàng
-
Tạp chí Y học Thành phố Hồ Chí Minh – Y học
Tạp chí Y học Thành phố Hồ Chí Minh
-
Journal of Tropical Science and Engineering
Journal of the Joint Vietnam - Russia Tropical Science and Technology Research Center/Ministry of National Defence
-
Tạp chí Khoa học và Công nghệ nhiệt đới
Tạp chí của Trung tâm Nhiệt đới Việt – Nga, Bộ Quốc phòng
-
Tạp chí Diễn dàn Văn nghệ Việt Nam
Ấn phẩm của Thời báo Văn học nghệ thuật, thuộc Liên hiệp các Hội văn học nghệ thuật Việt Nam
-
Tạp chí Cầu đường Việt Nam
Tạp chí của Hội Khoa học Kỹ thuật Cầu đường Việt Nam
-
Tạp chí Khoa học Đo đạc và Bản đồ
Tạp chí của Viện Khoa học Đo đạc và Bản đồ
-
Tạp chí Chính trị và Phát triển
Tạp chí của Nhà xuất bản Chính trị quốc gia Sự thật
-
Tạp chí Khoa học Huflit
Tạp chí của Trường Đại học Ngoại ngữ - Tin học Thành phố Hồ Chí Minh
-
Tạp chí Nguồn sáng dân gian
Tạp chí của Hội Văn nghệ dân gian Việt Nam
-
Tạp chí Khoa học Quản lý và Công nghệ
Tạp chí của Trường Đại học Công nghệ và Quản lý Hữu Nghị
-
Tạp chí Lý luận chính trị Công an nhân dân
Tạp chí của Học viện Chính trị Công an nhân dân
-
Tạp chí Nuclear Science and Technology
Tạp chí của Hội Năng lượng nguyên tử Việt Nam
-
Tạp chí Khoa học Quốc tế Agu
Tạp chí của Trường Đại học An Giang, ĐHQG-HCM
-
Tạp chí Ngân hàng
Tạp chí của Thời báo Ngân hàng - Ngân hàng Nhà nước Việt Nam
-
Tạp chí khoa học Trường Đại học Quảng Nam
Tạp chí của Trường Đại học Quảng Nam
-
Tạp Chí Y học thảm họa và Bỏng
Tạp chí của Bệnh viện Bỏng Quốc gia Lê Hữu Trác, Hội Bỏng Việt Nam
-
Tạp chí Pháp luật và Phát triển
Tạp chí của Viện Nghiên cứu Pháp luật và kinh tế Asean, Hội Luật gia Việt Nam
-
Tạp chí Kiểm nghiệm Dược và Mỹ phẩm
Tạp chí của Viện Kiểm nghiệm thuốc Trung ương
-
Tạp chí Khoa học Tài chính - Ngân hàng Hà Nội
Tạp chí của Trường Đại học Tài chính - Ngân hàng Hà Nội
-
Tạp chí Khoa học Trường Đại học Sài Gòn
Tạp chí của Trường Đại học Sài Gòn
-
Tạp chí Khoa học giáo dục Kỹ thuật - Hậu cần
Tạp chí của Học viện Kỹ thuật và Công nghệ an ninh
-
Tạp chí Khoa học và Giáo dục an ninh
Tạp chí của Học viện An ninh nhân dân -Bộ Công an
-
Tạp chí Khoa học giáo dục Cảnh sát nhân dân
Tạp chí của Trường Đại học Cảnh sát nhân dân
-
Tạp chí Khoa học Tài chính Kế toán
Tạp chí của Trường Đại học Tài chính - Kế toán
-
Tạp chí Giáo dục lý luận
Tạp chí của Học viện Chính trị khu vực I – Học viện Chính trị quốc gia Hồ Chí Minh
-
Tạp chí Kinh tế và Quản lý
Tạp chí của Học viện Chính trị quốc gia Hồ Chí Minh
-
Tạp chí Kinh tế Châu Á – Thái Bình Dương
Tạp chí của Trung tâm Kinh tế Châu Á – Thái Bình Dương
-
Tạp chí Nghiên cứu Hồ Chí Minh
Tạp chí của Viện Hồ Chí Minh và các lãnh tụ của Đảng - Học viện Chính trị quốc gia Hồ Chí Minh
-
Tạp chí Lý luận, phê bình Văn học, nghệ thuật
Tạp chí của Hội đồng Lý luận Trung ương
-
Tạp chí Lịch sử Đảng
Tạp chí của Viện Lịch sử Đảng, Học viện Chính trị quốc gia Hồ Chí Minh
-
Journal of Vietnam Communist Party’s History
Tạp chí của Viện Lịch sử Đảng, Học viện Chính trị quốc gia Hồ Chí Minh
-
Tạp chí Lý luận chính trị và Truyền thông. Kỳ Lý luận chính trị và Truyền thông
Tạp chí là cơ quan ngôn luận khoa học của Học viện Báo chí và Tuyên truyền
-
Tạp chí Lý luận chính trị và Truyền thông. Kỳ Lý luận chính trị và Truyền thông – Một số vấn đề lý luận chính trị và truyền thông trong thực tiễn nghiên cứu đào tạo
Tạp chí là cơ quan ngôn luận khoa học của Học viện Báo chí và Tuyên truyền
-
Journal of Political theory and Communication
Tạp chí là cơ quan ngôn luận khoa học của Học viện Báo chí và Tuyên truyền
-
Tạp chí điện tử Lý luận chính trị và Truyền thông (tiếng Việt)
Tạp chí là cơ quan ngôn luận khoa học của Học viện Báo chí và Tuyên truyền
-
Tạp chí điện tử Lý luận chính trị và Truyền thông (tiếng Anh)
Tạp chí là cơ quan ngôn luận khoa học của Học viện Báo chí và Tuyên truyền
-
Tạp chí Thị trường tài chính tiền tệ
Tạp chí của Hiệp hội Ngân hàng Việt Nam
-
Tạp chí Khoa học Trường Đại học Tân Trào
Tạp chí của Trường Đại học Tân Trào
-
Tạp chí Văn hóa và Nguồn lực
Tạp chí của Trường Đại học Văn hóa Thành phố Hồ Chí Minh
-
Tạp chí Nghiên cứu khoa học Hậu cần quân sự
Tạp chí của Học viện Hậu cần
-
Tạp chí Quản lý nhà nước
Tạp chí của Học viện Hành chính và Quản trị công
-
Journal of State Management
Tạp chí của Học viện Hành chính và Quản trị công
-
Tạp chí điện tử Quản lý nhà nước
Tạp chí của Học viện Hành chính và Quản trị công
-
Tạp chí Lịch sử quân sự
Tạp chí của Viện Chiến lược và Lịch sử quốc phòng Việt Nam
-
Journal of People’s Security
Tạp chí của Trường Đại học An ninh nhân dân
-
Vietnamese Journal of Dermatology and Venereology
Tạp chí của Hội Da liễu Việt Nam
-
Tạp chí Khoa học Pháp lý Việt Nam.
Tạp chí của Trường Đại học Luật Thành phố Hồ Chí Minh
-
Tạp chí Khoa học Pháp lý Việt Nam - Khoa học xã hội và Kinh tế
Tạp chí của Trường Đại học Luật Thành phố Hồ Chí Minh
-
Vietnamese Journal of Legal Science
Tạp chí của Trường Đại học Luật Thành phố Hồ Chí Minh
-
Vietnam Journal of Educational Sciences
Tạp chí của Viện Khoa học Giáo dục Việt Nam
-
Tạp chí Khoa học Giáo dục Việt Nam
Tạp chí của Viện Khoa học Giáo dục Việt Nam
-
Tạp chí Phòng cháy và Chữa cháy
Tạp chí của Trường Đại học Phòng cháy Chữa cháy
-
Tạp chí Phòng cháy và Chữa cháy điện tử
Tạp chí của Trường Đại học Phòng cháy chữa cháy
-
Tạp chí Khoa học và Đào tạo Thể dục thể thao
Tạp chí của Trường Đại học Thể dục thể thao Thành phố Hồ Chí Minh
-
Tạp chí Khoa học – Công nghệ Thủy sản
Tạp chí Khoa học của Trường Đại học Nha Trang
-
Academia Journal of Biology
Tạp chí của Viện Khoa học sự sống, Viện Hàn lâm Khoa học và Công nghệ Việt Nam
-
Vietnam Journal of Marine Science and Technology
Tạp chí của Viện Hải dương học, Viện Hàn lâm Khoa học và Công nghệ Việt Nam
-
Tạp chí Thanh niên nghiên cứu khoa học
Tạp chí của Trung ương Đoàn TNCS Hồ Chí MInh
-
Tạp chí Nghiên cứu Chiến thuật - Chiến dịch
Tạp chí của Học viện Lục quân
-
Tạp chí khoa học công nghệ và phát triển
Tạp chí của Trường Đại Học Đông Đô
-
Tạp chí Nghiên cứu Công nghiệp và Thương mại
Tạp chí của Viện Nghiên cứu Chiến lược, Chính sách Công Thương – Bộ Công Thương
-
Vietnam Journal of Surgery and Endolaparosurgery
Tạp chí của Hội Ngoại khoa và Phẫu thuật nội soi Việt Nam
-
Tạp chí Ngoại khoa và Phẫu thuật nội soi Việt Nam
Tạp chí của Hội Ngoại khoa và Phẫu thuật nội soi Việt Nam
-
Thang Long Journal of Science: Mathematics and Mathematical Sciences
Tạp chí của Trường Đại học Thăng Long
-
Thang Long Journal of Science: Van hien and Heritage
Tạp chí của Trường Đại học Thăng Long
-
Tạp chí Khoa học Thăng Long – Khoa học ứng dụng
Tạp chí của Trường Đại học Thăng Long
-
Tạp chí Quy hoạch đô thị
Tạp chí của Hội Quy hoạch phát triển đô thị Việt Nam.
-
Tạp chí Công nghiệp Nông thôn
Tạp chí của Hội Cơ khí Nông nghiệp Việt Nam
-
Vietnam Journal of Preventive Medicine
Tạp chí của Hội Y học dự phòng Việt Nam
-
Tạp chí Nghiên cứu lập pháp
Tạp chí Nghiên cứu lập pháp của Văn phòng Quốc hội.
-
Journal of 108 clinical medicine and pharmacy
Viện Nghiên cứu khoa học y dược lâm sàng 108 – Bệnh viện Trung ương Quân đội 108
-
Tạp chí Y dược lâm sàng 108
Tạp chí của Viện Nghiên cứu khoa học y dược lâm sàng 108 – Bệnh viện TWQĐ 108
-
Tạp chí Khoa học và Giáo dục: Khoa học Giáo dục
Tạp chí của Trường Đại học Sư phạm, Đại học Huế
-
Tạp chí Khoa học và Giáo dục: Số đặc biệt
Tạp chí của Trường Đại học Sư phạm, Đại học Huế
-
Tạp chí Khoa học và Giáo dục
Tạp chí của Trường Đại học Sư phạm, Đại học Huế
-
Tạp chí Giáo dục và Xã hội
Tạp chí của Viện Nghiên cứu và Ứng dụng công nghệ Giáo dục ATEC thuộc Hiệp hội các trường Đại học, Cao đẳng Việt Nam
-
REV Journal on Electronics and Communications
Journal of The Radio and Electronics Assiciation of Viet Nam
-
Tạp chí Khoa học Kiểm định Vắc xin và Sinh phẩm y tế
Tạp chí của Viện Kiểm định Quốc gia Vắc xin và Sinh phẩm y tế
-
Journal of Science Control Vaccine and Biologicals
Tạp chí của Viện Kiểm định Quốc gia Vắc xin và Sinh phẩm y tế
-
Tạp chí Thông tin và Viễn thông
Tạp chí của Trường Đại học Tôn Đức Thắng
Print ISSN: 2475-1839 Online ISSN: 2475-1847
-
Tạp chí Công nghệ tiên tiến và Tính toán
Tạp chí của Trường Đại học Tôn Đức Thắng
-
Tạp chí Kinh tế - Công nghiệp
Tạp chí của Trường Đại học Kinh tế Công nghiệp Long An
-
Tạp chí Nghiên cứu Văn hóa và Phát triển
Tạp chí của Viện Văn hóa và Phát triển, Học viện Chính trị quốc gia Hồ Chí Minh.
-
Tạp chí Khoa học Trường Đại học Phan Thiết
Tạp chí của Trường Đại học Phan Thiết
-
Journal of Water Resources and Environmental Engineering
Tạp chí của Trường Đại học Thủy lợi
-
Tạp chí khoa học Trường Đại học Hà Tĩnh
Tạp chí của Trường Đại học Hà Tĩnh
-
Tạp chí Khoa học: Vật liệu và Linh kiện tiên tiến
Tạp chí của Đại học Quốc gia Hà Nội
-
Tạp chí Khoa học: Khoa học Tự nhiên và Công nghệ
Tạp chí của Đại học Quốc gia Hà Nội
-
Tạp chí Khoa học: Các Khoa học Trái đất và Môi trường
Tạp chí của Đại học Quốc gia Hà Nội
-
Tạp chí Khoa học: Công nghệ Thông tin và Truyền thông
Tạp chí của Đại học Quốc gia Hà Nội
-
Tạp chí Khoa học: Nghiên cứu Giáo dục
Tạp chí của Đại học Quốc gia Hà Nội
-
Tạp chí Khoa học: Nghiên cứu Chính sách và Quản lý
Tạp chí của Đại học Quốc gia Hà Nội
-
Tạp chí Khoa học và công nghệ Trường Đại học Hải Dương
Tạp chí của Trường Đại học Hải Dương
-
Vietnam Journal of Infectious Diseases
Journal of Society for Infection Diseases
-
Hue Journal of Economics and Management
Journal of University of Economics, Hue University
-
Tạp chí Khoa học Quản lý và Kinh tế
Tạp chí của Trường Đại học Kinh tế, Đại học Huế
-
Tạp chí Nguồn nhân lực và An sinh xã hội
Tạp chí của Trường Đại học Lao động - Xã hội
-
Tạp chí Khoa học tình báo quốc phòng
Tạp chí của Viện Nghiên cứu Khoa học Tình báo/Học viện Khoa học Quân sự
-
Tạp chí Nghiên cứu Mỹ thuật
Tạp chí của Trường Đại học Mỹ thuật Việt Nam
-
Tạp chí Pháp luật về Quyền con người - Chuyên đề
Tạp chí của Viện Quyền con người
-
Vietnam Journal of Human Rights Law
Journal of Institute of Human Rights
-
Tạp chí Pháp luật về Quyền con người (Bản điện tử)
Tạp chí của Viện Quyền con người
-
Tạp chí Khoa học và Công nghệ Nông nghiệp
Tạp chí của Trường Đại học Nông Lâm, Đại học Huế
-
Tạp chí Phẫu thuật tim mạch và lồng ngực Việt Nam
Tạp chí của Hội Phẫu thuật tim mạch và lồng ngực Việt Nam
-
Journal of Forestry Science and Technology
Journal of Vietnam National University of Forestry
-
Tạp chí Khoa học và Công nghệ Lâm nghiệp
Tạp chí của Trường Đại học Lâm nghiệp
-
Tạp chí Khoa học giáo dục thể chất và thể thao trường học
Tạp chí của Trường Đại học Sư phạm Thể dục Thể thao Hà Nội
-
Tạp chí Khoa học và Công nghệ Ứng dụng
Tạp chí của Trường Đại học Sư phạm Kỹ thuật Hưng Yên
-
Tạp chí Khoa học và Công nghệ Trường Đại học Khoa học, Chuyên san Hóa - Sinh - Khoa học trái đất
Tạp chí của Trường Đại học Khoa học, Đại học Huế
-
Tạp chí Khoa học và Công nghệ Trường Đại học Khoa học, Chuyên san Văn - Sử - Triết học
Tạp chí của Trường Đại học Khoa học, Đại học Huế
-
Tạp chí Khoa học và Công nghệ Trường Đại học Khoa học, Chuyên san Toán - CNTT - Vật lý - Kiến trúc
Tạp chí của Trường Đại học Khoa học, Đại học Huế
-
Tạp chí Khoa học và công nghệ Trường Đại học Hùng Vương
Tạp chí của Trường Đại học Hùng Vương
-
Tạp chí Y học Quân sự
Cơ quan thông tin, lý luận, nghiệp vụ của ngành Quân y
-
Tạp chí Y Dược cổ truyền Việt Nam
Tạp chí của Học viện Y - Dược học cổ truyền Việt Nam
-
Tạp chí Nghiên cứu Dược và Thông tin thuốc
Tạp chí của Trường Đại học Dược Hà Nội
-
Mekong University Scientific Journal
Tạp chí Khoa học Đại học Cửu Long phiên bản Tiếng Anh
-
Tạp chí Khoa học và Công nghệ Y khoa
Tạp chí của Trường Đại học Lương Thế Vinh
-
Vietnam Journal of Nutrition and Food
Journal of Vietnam Nutrition Association
-
Tạp chí khoa học Trường Đại học Hoa Lư
Tạp chí của Trường Đại học Hoa Lư
-
Tạp chí Y Dược Thái Bình (Thai Binh Journal of Medicine and Pharmacy)
Tạp chí của Trường Đại học Y Dược Thái Bình
-
Tạp chí Khoa học – Đại học Đồng Nai
Tạp chí của Trường Đại học Đồng Nai
-
Tạp chí Truyền thống và Phát triển – Chuyên đề: Nguồn lực và Phát triển
Tạp chí của Viện Nghiên cứu Truyền thống và Phát triển.
-
Vietnamese Journal of Neurology
Journal of Vietnam Neurological Association
-
Tạp chí Khoa học và công nghệ Nông nghiệp Việt Nam
Tạp chí của Viện Khoa học Nông nghiệp Việt Nam
-
Tạp chí Pháp lý
Tạp chí của Viện Khoa học Pháp lý và Kinh doanh Quốc tế
-
Tạp chí Giáo dục lý luận Chính trị Quân sự
Tạp chí của Học viện Chính trị, Bộ Quốc phòng
-
Hue Journal of Medicine and Pharmacy
Journal of Hue University of Medicine and Pharmacy
-
Journal of Military Pharmaco-Medicine
Journal of Vietnam Military Medical University
-
Tạp chí Thông tin khoa học lý luận chính trị
Tạp chí của Viện Thông tin khoa học, Học viện Chính trị quốc gia Hồ Chí Minh
-
Tạp chí Thông tin khoa học lý luận chính trị - Những vấn đề lý luận phục vụ lãnh đạo
Tạp chí của Viện Thông tin khoa học, Học viện Chính trị quốc gia Hồ Chí Minh
-
Tạp chí Nghiên cứu Châu Á – Thái Bình Dương
Tạp chí của Viện Nghiên cứu Châu Á - Thái Bình Dương
-
Engineering and Technology for Sustainable Development (ETSD)
Tạp chí của Đại học Bách khoa Hà Nội
-
Journal of Sciences and Technology - Smart Systems and Devices
Tạp chí của Đại học Bách khoa Hà Nội
-
Tạp chí Nghề cá sông Cửu Long
Tạp chí của Viện Nghiên cứu Nuôi trồng thủy sản II
-
Tạp chí Khoa học Lâm nghiệp
Tạp chí của Viện Khoa học Lâm nghiệp Việt Nam
-
Tạp chí Kinh tế và Quản trị kinh doanh
Tạp chí của Trường Đại học Kinh tế và Quản trị Kinh doanh, Đại học Thái Nguyên
-
Tạp chí Nội tiết & Đái tháo đường
Tạp chí của Hội Nội tiết & Đái tháo đường Việt Nam
-
Journal of Diabetes and Endocrinology
Tạp chí của Hội Nội tiết & Đái tháo đường Việt Nam
-
Vietnam Archaeology
Journal of Vietnam Academy of Social Sciences - Institute of Archaeology
-
Tạp chí Quy hoạch xây dựng
Tạp chí Quy hoạch xây dựng là cơ quan ngôn luận của ngành Xây dựng về lĩnh vực quy hoạch và phát triển đô thị.
-
Journal of Social Sciences and Humanities
VNU Journal of University of Social Sciences and Humanities
-
Tạp chí Khoa học Xã hội và Nhân văn
Tạp chí của Trường Đại học Khoa học Xã hội và Nhân văn
-
Tạp chí Khoa học và Công nghệ Việt Nam - A
Tạp chí của Bộ Khoa học và Công nghệ
-
Tạp chí Khoa học và Công nghệ Việt Nam - B
Tạp chí của Bộ Khoa học và Công nghệ
-
Vietnam Journal of Science, Technology and Engineering - C
Tạp chí của Bộ Khoa học và Công nghệ
-
VMOST Journal of Social Sciences and Humanities - D
Tạp chí của Bộ Khoa học và Công nghệ
-
Tạp chí Khoa học Xã hội Việt Nam
Tạp chí của Viện Hàn lâm Khoa học xã hội Việt Nam
-
Vietnam Social Sciences
Tạp chí của Viện Hàn lâm Khoa học xã hội Việt Nam
-
Tạp chí Khoa học - Trường Đại học Sư phạm TP Hồ Chí Minh
Tạp chí của Trường Đại học Sư phạm TP Hồ Chí Minh
-
Tạp chí Khoa học và Công nghệ - Đại học Nguyễn Tất Thành
Tạp chí của Trường Đại học Nguyễn Tất Thành
-
Tạp chí Khoa học Tài nguyên và Môi trường
Tạp chí của Trường Đại học Tài nguyên và Môi trường Hà Nội
-
Journal Science and Technology Water Resources
Tạp chí của Viện Khoa học Thủy lợi Việt Nam
-
Tạp chí Khoa học và Công nghệ Thủy lợi
Tạp chí của Viện Khoa học Thủy lợi Việt Nam
-
Tạp chí Khoa học Kỹ thuật Mỏ - Địa chất
Tạp chí của Trường Đại học Mỏ - Địa chất
-
Vietnam Journal of Hydrometeorology
Tạp chí của Tổng Cục Khí tượng Thủy văn
-
Tạp chí Khoa học Biến đổi khí hậu
Tạp chí của Viện Khoa học Khí tượng Thủy văn và Biến đổi khí hậu
-
Tạp chí Khoa học và Công nghệ - Đại học Thái Nguyên
Tạp chí của Trường Đại học Thái Nguyên
-
Tạp chí Khoa học - Đại học Thủ Dầu Một
Tạp chí của Trường Đại học Thủ Dầu Một
-
Tạp chí Thông tin và Tư liệu
Tạp chí của Viện Thông tin và Thống kê khoa học và công nghệ
-
Tạp chí Nghiên cứu Khoa học và Công nghệ quân sự
Tạp chí của Viện Khoa học và Công nghệ quân sự
https://online.jmst.info/index.php/jmst -
Tạp chí Nghiên cứu Khoa học và Phát triển
Tạp chí của Trường Đại học Thành Đô
-
Tạp chí Khoa học Điều dưỡng
Tạp chí của Trường Đại học Điều dưỡng Nam Định
-
Tạp chí Khoa học Nghiên cứu Sức khỏe và Phát triển
Tạp chí của Trường Đại học Y tế công cộng
-
Journal of Health Sciences
Tạp chí của Trường Đại học Y Dược Hải Phòng
-
Vietnam Journal of Public Health
Tạp chí của Hội Y tế Công cộng Việt Nam
-
Tạp chí Khoa học - Trường Đại học Thủ đô Hà Nội: Khoa học Xã hội và Giáo dục
Tạp chí của Trường Đại học Thủ đô Hà Nội
-
Tạp chí Khoa học và Công nghệ Giao thông
Tạp chí của Trường Đại học Công nghệ Giao thông Vận tải
-
Journal of Science and Transport Technology
Tạp chí của Trường Đại học Công nghệ Giao thông vận tải
-
Tạp chí Khoa học - Trường Đại học Thủ đô Hà Nội: Khoa học Tự nhiên và Công nghệ
Tạp chí của Trường Đại học Thủ đô Hà Nội
-
Tạp chí điện tử Khoa học và Công nghệ QUI
Tạp chí của Trường Đại học Công nghiệp Quảng Ninh
-
Tạp chí Khoa học và Công nghệ Năng lượng
Tạp chí của Trường Đại học Điện lực
-
Tạp chí Khoa học Kiến trúc & Xây dựng
Tạp chí của Trường Đại học Kiến trúc Hà Nội
-
Tạp chí Khoa học Trường Đại học Hoa Sen
Tạp chí của Trường Đại học Hoa Sen
-
Journal of Science and Technique
Tạp chí của Trường Đại học Kỹ thuật Lê Quý Đôn
-
Journal of Science and Technique: Section on Special Construction Engineering
Tạp chí của Trường Đại học Kỹ thuật Lê Quý Đôn
-
Journal of Science and Technique: Section on Physics and Chemical Engineering
Tạp chí của Trường Đại học Kỹ thuật Lê Quý Đôn
-
Journal of Science and Technique: Section on Information and Communication Technology
Tạp chí của Trường Đại học Kỹ thuật Lê Quý Đôn
-
Tạp chí Chủ nghĩa xã hội – Lý luận và Thực tiễn
Tạp chí của Viện Chủ nghĩa xã hội khoa học, Học viện Chính trị quốc gia Hồ Chí Minh
-
Tạp chí Thông tin khoa học chính trị
Tạp chí của Học viện Chính trị khu vực IV
-
Tạp chí Khoa học Công nghệ Hàng Không
Tạp chí của Học Viện Hàng không Việt Nam
-
Tạp chí Luyện Kim - Khoa học vật liệu
Tạp chí của Hội Khoa học – Kỹ thuật Đúc – Luyện kim Việt Nam
-
Tạp chí Khoa học Trường Đại học Bà Rịa - Vũng Tàu
Tạp chí của Trường Đại học Bà Rịa - Vũng Tàu
-
Tạp chí Khoa học Trường Đại học Trà Vinh
Tra Vinh University Journal of Science (TVUJS)
-
Tạp chí Khoa học xã hội miền Trung
Tạp chí của Viện Hàn lâm Khoa học xã hội Việt Nam
-
Tạp chí Phát triển Khoa học & Công nghệ
Tạp chí của Đại học Quốc gia Thành phố Hồ Chí Minh
-
Science and Technology Development Journal
Tạp chí của Đại học Quốc gia Tp. Hồ Chí Minh
-
Tạp chí Phát triển Khoa học & Công nghệ: Kỹ thuật & Công nghệ
Tạp chí của Đại học Quốc gia Tp. Hồ Chí Minh
-
Tạp chí Phát triển Khoa học & Công nghệ: Khoa học Tự nhiên
Tạp chí của Đại học Quốc gia Tp. Hồ Chí Minh
-
Tạp chí Phát triển Khoa học & Công nghệ: Khoa học Trái đất và Môi trường
Tạp chí của Đại học Quốc gia Tp. Hồ Chí Minh
-
Tạp chí Phát triển Khoa học & Công nghệ: Khoa học Xã hội và Nhân văn
Tạp chí của Đại học Quốc gia Tp. Hồ Chí Minh
-
Tạp chí Phát triển Khoa học & Công nghệ: Khoa học - Kinh tế - Luật và Khoa học Quản lý
Tạp chí của Đại học Quốc gia TP Hồ Chí Minh
-
Tạp chí Khoa học Lạc Hồng- Chuyên san Kỹ thuật
Tạp chí của Trường Đại học Lạc Hồng
-
Tạp chí Khoa học Lạc Hồng- Chuyên san Xã hội
Tạp chí của Trường Đại học Lạc Hồng
-
Tạp chí Khoa học Lạc Hồng- Chuyên san Kinh tế
Tạp chí của Trường Đại học Lạc Hồng
-
Tạp chí Khoa học và Công nghệ - Trường Đại học Công nghiệp Thành phố Hồ Chí Minh
Tạp chí của Trường Đại học Công nghiệp Thành phố Hồ Chí Minh
-
Tạp chí Y Dược học Phạm Ngọc Thạch
Tạp chí của Trường Đại học Y Dược Phạm Ngọc Thạch
-
Tạp chí Môi trường
Tạp chí của Viện Chiến lược, Chính sách tài nguyên và Môi trường
-
Environment
Tạp chí của Viện Chiến lược, Chính sách tài nguyên và Môi trường
-
Tạp chí Môi trường - Chuyên đề Khoa học - Công nghệ
Tạp chí của Viện Chiến lược, chính sách tài nguyên và môi trường - Bộ Tài nguyên và Môi trường
-
Tạp chí Nông nghiệp và Môi trường
Tạp chí của Bộ Nông nghiệp và môi trường
-
Vietnam Journal of Agriculture and Environment
Tạp chí của Bộ Nông nghiệp và Môi trường
-
Tạp chí Khoa học Đại học Hạ Long
Tạp chí khoa học của Trường Đại học Hạ Long
-
Tạp chí Nông nghiệp và Phát triển
Tạp chí của Trường Đại học Nông Lâm Thành phố Hồ Chí Minh
-
Journal of Agriculture and Development
Tạp chí của Trường Đại học Nông Lâm Tp. Hồ Chí Minh
-
Tạp chí Khoa học và Phát triển (nay là Tạp chí Khoa học Nông nghiệp Việt Nam)
Tạp chí của Trường Đại học Nông nghiệp I Hà Nội (nay là Học Viện Nông nghiệp Việt Nam)
-
Tạp chí Khoa học Nông nghiệp Việt Nam
Tạp chí của Học Viện Nông nghiệp Việt Nam
-
Vietnam Journal of Agricultural Sciences
Tạp chí của Học viện Nông nghiệp Việt Nam
-
Tạp chí Khoa học Giáo dục Kỹ thuật
Tạp chí của Trường Đại học Sư phạm Kỹ thuật Thành phố Hồ Chí Minh
-
Journal of Technical Education Science
Tạp chí của Trường Đại học Sư phạm Kỹ thuật Thành phố Hồ Chí Minh
-
Journal of Technology & Innovation (JTIN)
Tạp chí của Đại học Công nghệ Tp. Hồ Chí Minh (HUTECH)
-
Tạp chí Kế toán và Kiểm toán
Tạp chí của Hiệp hội Kế toán và Kiểm toán Việt Nam
-
Tạp chí Khoa học Trường Đại học Mở Hà Nội
Tạp chí của Trường Đại học Mở Hà Nội
-
Journal of International Economics and Management
Tạp chí của Trường Đại học Ngoại thương
-
Tạp chí Quản lý và Kinh tế quốc tế
Tạp chí của Trường Đại học Ngoại thương
-
Tạp chí Khoa học & Công nghệ, Trường Đại học Kinh tế - Kỹ thuật Công nghiệp
Tạp chí của Trường Đại học Kinh tế - Kỹ thuật Công nghiệp
-
Tạp chí Khoa học - Trường Đại học Cửu Long
Tạp chí của Trường Đại học Cửu Long
-
Tạp chí Khoa học và Công Nghệ Trường Đại học Xây dựng Miền Tây
Tạp chí của Trường Đại học Xây dựng Miền Tây
-
Tạp chí Khoa học và Công nghệ Trường Đại học Hòa Bình
Tạp chí của Trường Đại học Hòa Bình.
-
Science and Technology Policy and Management
Tạp chí của Học viện Khoa học, Công nghệ và Đổi mới sáng tạo
-
Tạp chí Chính sách và Quản lý Khoa học và Công nghệ
Tạp chí của Học viện Khoa học, Công nghệ và Đổi mới sáng tạo
-
Tạp chí Khoa học Công nghệ Hàng hải
Tạp chí của Trường Đại học Hàng hải Việt Nam
-
Tạp chí Khoa học và công nghệ - Trường Đại học Thành Đông
Tạp chí của Trường Đại học Thành Đông
-
Tạp chí Khoa học- Trường Đại học Phú Yên
Tạp chí của Trường Đại học Phú Yên
-
Tạp chí Khoa học Đại học Khánh Hòa
Tạp chí của Trường Đại học Khánh Hòa
-
Tạp chí Khoa học Trường Đại học Quy Nhơn
Tạp chí Khoa học Trường Đại học Quy Nhơn thuộc Trường Đại học Quy Nhơn
-
Tạp chí Khoa học Xã hội, Nhân văn và Giáo dục
Tạp chí của Trường Đại học Sư phạm - Đại học Đà Nẵng
-
Tạp chí Lãnh đạo và Chính sách
Tạp chí của Viện Lãnh đạo học và Hành chính công, Học viện Chính trị quốc gia Hồ Chí Minh
-
Tạp chí Pháp luật và Thực tiễn
Tạp chí của Trường Đại học Luật - Đại học Huế
-
Tạp chí Nghiên cứu và Phát triển
Tạp chí của Viện Nghiên cứu phát triển Thừa Thiên Huế
-
Tạp chí Khoa học và Đào tạo Ngân hàng (nay là Tạp chí Kinh tế - Luật và Ngân hàng)
Tạp chí của Học viện Ngân hàng
-
Journal of Economic and Banking Studies
Tạp chí của Học viện Ngân hàng
-
Tạp chí Kinh tế và Ngân hàng châu Á
Tạp chí của Trường Đại học Ngân hàng Tp. Hồ Chí Minh
-
Asian Journal of Economics and Banking (AJEB)
Tạp chí của Trường Đại học Ngân hàng Tp. Hồ Chí Minh
-
Tạp chí Nghiên cứu Tài chính – Marketing
Tạp chí của Trường Đại học Tài chính - Marketing
-
Tạp chí Nghiên cứu khoa học – Đại học Sao Đỏ
Tạp chí của Trường Đại học Sao Đỏ
-
Tạp chí Khoa học Đại học Cần Thơ
Tạp chí của Trường Đại học Cần Thơ
https://ctujsvn.ctu.edu.vn/ -
CTU Journal of Innovation and Sustainable Development
Tạp chí của Trường Đại học Cần Thơ
https://ctujs.ctu.edu.vn/ -
Tạp chí Khoa học và Công nghệ Cần Thơ
Tạp chí của Trường Đại học Kỹ thuật - Công nghệ Cần Thơ
-
Journal of Science and Development Economics
Journal of Nam Can Tho University
-
Tạp chí Khoa học và Kinh tế Phát triển
Tạp chí của Trường Đại học Nam Cần Thơ
-
Tạp chí Kinh tế & Phát triển
Tạp chí của Trường Đại học Kinh tế Quốc dân
-
Journal of Economics and Development
Tạp chí của Trường Đại học Kinh tế Quốc dân
-
Tạp chí Kiểm nghiệm và An toàn thực phẩm
Tạp chí của Viện Kiểm nghiệm an toàn vệ sinh thực phẩm quốc gia
-
Vietnam Journal of Food Control
Tạp chí của Viện Kiểm nghiệm An toàn Vệ sinh Thực phẩm Quốc gia
-
Tạp chí Khoa học và Công nghệ trong lĩnh vực An toàn thông tin
Ấn phẩm của Tạp chí An toàn Thông tin - Ban Cơ yếu Chính phủ
-
Tạp chí Tâm lý – Giáo dục
Tạp chí của Hội Khoa học Tâm Lý – Giáo dục Việt Nam
https://tamlygiaoduc.com.vn/category/xuat-ban-khoa-hoc -
Hong Duc University Journal of Science
Tạp chí của Trường Đại học Hồng Đức
-
Tạp chí Khoa học Trường Đại học Hồng Đức – Khoa học Tự nhiên, Kỹ thuật và Công nghệ
Tạp chí của Trường Đại học Hồng Đức
-
Tạp chí Khoa học Trường Đại học Hồng Đức – Khoa học Xã hội và Nhân văn
Tạp chí của Trường Đại học Hồng Đức
-
Tạp chí Khoa học Trường Đại học Hồng Đức – Khoa học Nông - Lâm - Ngư nghiệp
Tạp chí của Trường Đại học Hồng Đức
-
Tạp chí Khoa học Trường Đại học Hồng Đức – Kinh tế - Quản trị kinh doanh, Chính trị và Pháp luật
Tạp chí của Trường Đại học Hồng Đức
-
Tạp chí Khoa học Trường Đại học Hồng Đức – Khoa học Giáo dục và Quản lý
Tạp chí của Trường Đại học Hồng Đức
-
Tạp chí Khoa học - Trường Đại học Hồng Đức
Tạp chí của Trường Đại học Hồng Đức
-
Hong Duc University Journal of Science
Tạp chí của Trường Đại học Hồng Đức
-
Tạp chí Khoa học- Trường Đại học Văn hóa, Thể thao và Du lịch Thanh Hóa
Tạp chí của Trường Đại học Văn hóa, Thể thao và Du lịch Thanh Hóa
-
Tạp chí Y học lâm sàng Bệnh viện Trung ương Huế
Tạp chí của Bệnh viện Trung ương Huế
https://jcmhch.com.vn -
Journal of Clinical Medicine – Hue Central Hospital
Tạp chí của Bệnh viện Trung ương Huế
https://jcmhch.com.vn/ -
Tạp chí Khoa học và Công nghệ Trường Đại học Phạm Văn Đồng
Tạp chí của Trường Đại học Phạm Văn Đồng
-
Tạp chí Kinh tế & Kinh doanh
Tạp chí của Trường Đại học Kinh tế - Đại học Quốc gia Hà Nội
-
Tạp chí Nghiên cứu Nước ngoài
Tạp chí của Trường Đại học Ngoại ngữ - Đại học Quốc gia Hà Nội
-
Tạp chí Khoa học Kinh tế
Tạp chí của Trường Đại học Kinh tế- Đại học Đà Nẵng
-
Tạp chí Khoa học - Trường Đại học Hải Phòng: Giáo dục - Xã hội - Nhân văn
Tạp chí của Trường Đại học Hải Phòng
-
Tạp chí Khoa học - Trường Đại học Hải Phòng: Kinh tế và Kỹ thuật - Công nghệ
Tạp chí của Trường Đại học Hải Phòng
-
Haiphong University Journal of Science
Tạp chí của Trường Đại học Hải Phòng
-
Tạp chí Kinh doanh và Công nghệ
Tạp chí của Trường Đại học Kinh doanh và Công nghệ Hà Nội
-
Tạp chí Khoa học - Trường Đại học Sư phạm Hà Nội: Khoa học Tự nhiên
Tạp chí của Trường Đại học Sư phạm Hà Nội
-
Tạp chí Khoa học - Trường Đại học Sư phạm Hà Nội: Khoa học Xã hội
Tạp chí của Trường Đại học Sư phạm Hà Nội
-
Tạp chí Khoa học - Trường Đại học Sư phạm Hà Nội: Khoa học Giáo dục
Tạp chí của Trường Đại học Sư phạm Hà Nội
-
Tạp chí Khoa học Trường Đại học Sư phạm Hà Nội 2: Chuyên san Khoa học Tự nhiên và Công nghệ
Tạp chí của Trường Đại học Sư phạm Hà Nội 2
-
Tạp chí Khoa học Trường Đại học Sư phạm Hà Nội 2: Chuyên san Khoa học giáo dục
Tạp chí Khoa học Trường Đại học Sư phạm Hà Nội 2
-
Tạp chí Khoa học Trường Đại học Sư phạm Hà Nội 2: Chuyên san Khoa học xã hội và nhân văn
Tạp chí của Trường Đại học Sư phạm Hà Nội 2
-
Tạp chí Khoa học Giao thông vận tải
Tạp chí của Trường Đại học Giao thông vận tải
-
Transport and Communications Science Journal
Tạp chí của Trường Đại học Giao thông vận tải
-
Tạp chí Phân tích Hóa, Lý và Sinh học
Tạp chí của Hội Khoa học Kỹ thuật Phân tích Hóa, Lý và Sinh học
-
Tạp chí Khoa học Đại học Công Thương
Trường Đại học Công Thương Tp. Hồ Chí Minh
-
Tạp chí Khoa học Công nghệ và Thực phẩm (nay là Tạp chí Khoa học Đại học Công Thương)
Tạp chí của Trường Đại học Công nghiệp Thực phẩm Tp. Hồ Chí Minh (nay là Trường Đại học Công Thương Tp. Hồ Chí Minh)
-
Tạp chí Khoa học- Đại học Văn Hiến
Tạp chí của Trường Đại học Văn Hiến
-
Tạp chí Khoa học - Đại học Văn Lang
Tạp chí của Trường Đại học Văn Lang
-
Tạp chí Khoa học Kỹ thuật Chăn nuôi
 Tạp chí của Hội Chăn nuôi Việt Nam
Tạp chí của Hội Chăn nuôi Việt Nam -
Tạp chí Triết học và Đời sống
Tạp chí của Viện Triết học, Học viện Chính trị Quốc gia Hồ Chí Minh
-
Tạp chí Nghiên cứu khoa học và Phát triển kinh tế
Tạp chí của Trường Đại học Tây Đô
-
Journal of research and development on information and communication technology
Tạp chí của Bộ Thông tin và Truyền thông (nay là Bộ Khoa học và Công nghệ)
-
Tạp chí Thông tin và Truyền thông: chuyên san các công trình nghiên cứu, phát triển và ứng dụng công nghệ thông tin và truyền thông
Tạp chí của Bộ Thông tin và Truyền thông (nay là Bộ Khoa học và Công nghệ)
-
Tạp chí Nghiên cứu Dân tộc
Tạp chí của Học viện Dân tộc, Ủy ban Dân tộc
-
Tạp chí Thông tin Khoa học xã hội
Tạp chí của Viện Thông tin Khoa học xã hội, Viện Hàn lâm Khoa học xã hội Việt Nam
-
Social Sciences Information Review
Tạp chí của Viện Thông tin KHXH- Viện Hàn lâm Khoa học xã hội Việt Nam
-
Tạp chí Khoa học Đại học Đồng Tháp: Khoa học Tự nhiên
Tạp chí của Trường Đại học Đồng Tháp
-
Tạp chí Khoa học Đại học Đồng Tháp: Khoa học Xã hội và Nhân văn
Tạp chí của Trường Đại học Đồng Tháp
-
Journal of Science and Technology in Civil Engineering
Tạp chí của Trường Đại học Xây dựng
-
Tạp chí Khoa học công nghệ Xây dựng
Tạp chí của Trường Đại học Xây dựng
-
Tạp chí Xây dựng và Đô thị
Tạp chí Xây dựng và Đô thị (ISSN 1859-3119), do Học viện Chiến lược, bồi dưỡng cán bộ xây dựng phát hành từ năm 2009, là tạp chí khoa học có phản biện. Tạp chí là diễn đàn học thuật công bố các kết quả nghiên cứu, nghiên cứu lý luận và ứng dụng thực tiễn trong các lĩnh vực xây dựng, kiến trúc, đô thị và giao thông vận tải. Tạp chí nhằm thúc đẩy trao đổi khoa học, hỗ trợ phát triển chuyên môn và đóng góp cho công tác quản lý, hoạch định chính sách trong lĩnh vực xây dựng và phát triển đô thị. Tạp chí áp dụng quy trình phản biện kín hai chiều, tuân thủ các nguyên tắc đạo đức xuất bản theo COPE và được lập chỉ mục trên Google Scholar và Vietnam Citation Gate.
-
Tạp chí Môi trường Đô thị Việt Nam
Tạp chí của Hiệp hội Môi trường Đô thị và Khu công nghiệp Việt Nam
-
Tạp chí Trắc địa – Bản đồ
Tạp chí của Hội Trắc địa – Bản đồ - Viễn thám Việt Nam
-
Vietnam Journal of Earth Sciences
Tạp chí của Viện Hàn lâm Khoa học và Công nghệ Việt Nam
-
Vietnam Journal of Chemistry
Tạp chí của Viện Hàn lâm Khoa học và công nghệ Việt Nam
-
Tạp chí Khoa học và Công nghệ
Tạp chí của Viện Hàn lâm Khoa học và Công nghệ Việt Nam
-
Vietnam Journal of Science and Technology
Tạp chí của Viện Hàn lâm Khoa học và Công nghệ Việt Nam
-
Tạp chí Khoa học Quản lý giáo dục
Tạp chí của Trường Cán bộ quản lý giáo dục Thành phố Hồ Chí Minh
-
Tạp chí Khoa học Học viện Phụ nữ Việt Nam
Tạp chí Khoa học của Học viện Phụ nữ Việt Nam
-
Tạp chí Khoa học - Đại học Huế
Tạp chí khoa học đa lĩnh vực của Trường Đại học Huế
-
Tạp chí Khoa học Đại học Huế: Khoa học Tự nhiên
Tạp chí của Đại học Huế
-
Tạp chí Khoa học Đại học Huế: Kinh tế và Phát triển
Tạp chí của Đại học Huế
-
Tạp chí Khoa học Đại học Huế: Kỹ thuật và Công nghệ
Tạp chí của Đại học Huế
-
Tạp chí Khoa học Đại học Huế: Nông nghiệp và Phát triển Nông thôn
Tạp chí của Đại học Huế
-
Tạp chí Khoa học Đại học Huế: Khoa học Trái đất và Môi trường
Tạp chí của Đại học Huế
-
Tạp chí Khoa học Đại học Huế: Khoa học, Xã hội và Nhân văn
Tạp chí của Đại học Huế
-
Tạp chí Khoa học - Trường Đại học Sư phạm, Đại học Huế
Tạp chí của Trường Đại học Sư phạm, Đại học Huế
-
Tạp chí Khoa học & Giáo dục - Trường Đại học Sư phạm, Đại học Huế
Tạp chí của Trường Đại học Sư phạm, Đại học Huế
-
Tạp chí Khoa học và Công nghệ- Trường Đại học Khoa học Huế
Tạp chí của Trường Đại học Khoa học Huế
-
Tạp chí Khoa học - Trường Đại học Mở Thành phố Hồ Chí Minh
Tạp chí của Trường Đại học Mở Thành phố Hồ Chí Minh
-
Tạp chí khoa học Đại học Mở Thành phố Hồ Chí Minh - Kỹ thuật và Công nghệ
Tạp chí của Trường Đại học Mở Thành phố Hồ Chí Minh
-
Tạp chí khoa học Đại học Mở Thành phố Hồ Chí Minh - Khoa học Xã hội
Tạp chí của Trường Đại học Mở Thành phố Hồ Chí Minh
-
Tạp chí Khoa học Đại học Mở Thành phố Hồ Chí Minh - Kinh tế và Quản trị kinh doanh
Tạp chí của Trường Đại học Mở Thành phố Hồ Chí Minh
-
Journal of Science
Tạp chí của Trường Đại học Mở Thành phố Hồ Chí Minh
-
Ho Chi Minh City Open University Journal of Science: Engineering and Technology
Tạp chí của Trường Đại học Mở Thành phố Hồ Chí Minh
-
Ho Chi Minh City Open University Journal of Science: Social Sciences
Tạp chí của Trường Đại học Mở Thành phố Hồ Chí Minh
-
Ho Chi Minh City Open University Journal of Science - Economics and Business Administration
Tạp chí của Trường Đại học Mở Thành phố Hồ Chí Minh
-
Ho Chi Minh City Open University Journal of Science - Advances in computional structures
Tạp chí của Trường Đại học Mở Thành phố Hồ Chí Minh
-
Tạp chí Khoa học - Trường Đại học Tây Bắc
Tạp chí của Trường Đại học Tây Bắc
-
Journal of Measurement, Control, and Automation
Tạp chí của Hội Tự động hóa Việt Nam
-
Tạp chí Điện quang và Y học hạt nhân Việt Nam
Hội Điện quang và Y học hạt nhân Việt Nam
-
Tạp chí Năng lượng Nhiệt
Tạp chí khoa học của Hội Khoa học Kỹ thuật Nhiệt Việt Nam
-
Tạp chí Xúc tác và Hấp Phụ Việt Nam
Tạp chí của Hội Khoa học Công nghệ Xúc tác và Hấp phụ Việt Nam
-
Tạp chí Công nghiệp Mỏ
Tạp chí của Hội Khoa học và Công nghệ Mỏ Việt Nam
-
Tạp chí Thông tin Khoa học và Công nghệ
Tạp chí của Sở Khoa học và Công nghệ Quảng Bình
-
Tạp chí Khoa học Đào tạo và Huấn luyện thể thao
Tạp chí của Trường Đại học Thể dục Thể thao Bắc Ninh
-
Tạp chí Khoa học thể thao
Tạp chí của Viện Văn hóa, nghệ thuật, thể thao và du lịch
-
Tạp chí Nghiên cứu Kinh tế và Kinh doanh châu Á
Tạp chí của Trường Đại học Kinh tế Tp. Hồ Chí Minh
-
JABES - Journal of Asian Business and Economic Studies
Tạp chí của Trường Đại học Kinh tế Tp. Hồ Chí Minh
-
Tạp chí Phát triển Kinh tế
Tạp chí của Trường Đại học Kinh tế Tp. Hồ Chí Minh
-
Journal of Finance & Accounting Research
Journal of Academy of Finance
-
Tạp chí Lý luận chính trị
Tạp chí của Học viện Chính trị quốc gia Hồ Chí Minh
-
Tạp chí Lý luận Chính trị
Tạp chí của Học viện Chính trị - Hành chính Quốc gia Hồ Chí Minh
-
Tạp chí Dân tộc học và Tôn giáo học
Tạp chí của Viện Dân tộc học và Tôn giáo học, Viện Hàn lâm Khoa học xã hội Việt Nam
Tên cũ: Nghiên cứu Tôn giáo: https://vjol.info.vn/index.php/rsr
Tên cũ: Dân tộc học: https://vjol.info.vn/index.php/tapchiviendantochoc -
Journal of Anthropology and Religious Studies
Tạp chí của Viện Dân tộc học và Tôn giáo học, Viện Hàn lâm Khoa học xã hội Việt Nam
Tên cũ: Religious studies: https://vjol.info.vn/index.php/nctg -
Tạp chí Dân tộc học (nay là tạp chí Dân tộc học và Tôn giáo học)
Tạp chí của Viện Dân tộc học và Tôn giáo học- Viện Hàn lâm Khoa học xã hội Việt Nam
-
Tạp chí Nghiên cứu Tôn Giáo (nay là Tạp chí Dân tộc học và Tôn giáo học)
Tạp chí của Viện Dân tộc học và Tôn giáo học- Viện Hàn lâm Khoa học xã hội Việt Nam
-
Religious studies
Tạp chí của Viện Dân tộc học và Tôn giáo học- Viện Hàn lâm Khoa học xã hội Việt Nam
-
Tạp chí Nghiên cứu Kinh tế
Tạp chí của Viện Kinh tế Việt Nam và Thế giới, Viện Hàn lâm Khoa học xã hội Việt Nam
Tên cũ: Tạp chí Nghiên cứu Kinh tế: https://vjol.info.vn/index.php/econst -
Vietnam’s Socio-Economic Development
Tạp chí của Viện Kinh tế Việt Nam và Thế giới, Viện Hàn lâm Khoa học xã hội Việt Nam
-
Tạp chí Những vấn đề kinh tế và chính trị thế giới
Là ấn phẩm của Tạp chí Nghiên cứu Kinh tế, thuộc Viện Kinh tế Việt Nam và Thế giới.
-
Tạp chí Khoa học Ngôn ngữ và Văn hóa
Tạp chí của Trường Đại học Ngoại ngữ, Đại học Huế
-
Tạp chí Thiết bị Giáo dục
Tạp chí của Hiệp hội Thiết bị Giáo dục Việt Nam
-
Tạp chí Khoa học và Đào tạo Thể thao
Tạp chí của Trường Đại học Thể dục Thể thao Đà Nẵng
-
Tạp chí Nghiên cứu Khoa học Công đoàn
Tạp chí của Trường Đại học Công đoàn
-
Tạp chí Ngôn ngữ
Tạp chí Ngôn ngữ là cơ quan ngôn luận của Viện Ngôn ngữ học và của ngành ngôn ngữ học (https://vienngonnguhoc.vass.gov.vn/tin-tuc/ngon-ngu.aspx), là diễn đàn học thuật, nơi trao đổi, công bố những công trình nghiên cứu lí luận thực tiễn về ngôn ngữ học, từ điển học, bách khoa thư của các nhà khoa học trong và ngoài nước. Ra đời từ năm 1969 đến nay, Tạp chí Ngôn ngữ là tạp chí có uy tín trong ngành.
Tạp chí Ngôn ngữ được Hội đồng Chức danh Giáo sư Nhà nước đưa vào Danh mục tạp chí khoa học được tính điểm ở các ngành, liên ngành: Ngôn ngữ học, Văn học, Luật học, Sử học, Khảo cổ học, Dân tộc học, Nhân học,Tâm lí học.
-
Tạp chí Vật liệu và Xây dựng
Tạp chí của Viện Vật liệu xây dựng - Bộ Xây dựng
-
Journal of Materials & Construction
Tạp chí của Viện Vật liệu xây dựng - Bộ Xây dựng
-
Tạp chí Khoa học công nghệ Giao thông vận tải
Tạp chí của Trường Đại học Giao thông vận tải Tp. Hồ Chí Minh
-
Tạp chí Khoa học xã hội Thành phố Hồ Chí Minh
Tạp chí của Viện Khoa học xã hội vùng Nam Bộ - Viện Hàn lâm Khoa học xã hội Việt Nam
-
Revue des sciences sociales de Ho Chi Minh
Tạp chí của Viện KHXH vùng Nam Bộ - Viện Hàn lâm Khoa học xã hội Việt Nam
-
Tạp chí Khoa học Phát triển nhân lực
Học viện Cán bộ Thành phố Hồ Chí Minh
-
Tạp chí Khoa học và Công nghệ - Trường Đại học Bình Dương
Tạp chí của Trường Đại học Bình Dương
-
Tạp chí Phát triển và Hội nhập
Tạp chí của Trường Đại học Kinh tế-Tài chính Tp. Hồ Chí Minh
-
Tạp chí Giáo dục Nghệ thuật
Tạp chí của Trường Đại học Sư phạm Nghệ thuật Trung ương
-
Chuyên san Phát triển Khoa học và Công nghệ Trẻ
Chuyên san của Trung tâm Phát triển Khoa học và Công nghệ Trẻ
-
Tạp chí Địa lý nhân văn và Phát triển bền vững. Kỳ: Phát triển bền vững Vùng
Viện Địa lý nhân văn và Phát triển bền vững, Viện Hàn lâm Khoa học xã hội Việt Nam
-
Tạp chí Địa lý nhân văn và Phát triển bền vững. Kỳ Nghiên cứu Địa lý nhân văn
Viện Địa lý nhân văn và Phát triển bền vững, Viện Hàn lâm Khoa học xã hội Việt Nam
-
Tạp chí Nghiên cứu Văn học
Tạp chí của Viện Văn học, Viện Hàn lâm Khoa học xã hội Việt Nam
-
Tạp chí Khoa học và Công nghệ- Đại học Công nghệ Đồng Nai
Trường Đại học Công nghệ Đồng Nai
-
Journal of Economic Development
Tạp chí của Trường Đại học Kinh tế TP Hồ Chí Minh
Công Nghiệp: Kinh tế & Quản lý (nay là Tạp chí Công thương)
Tạp chí của Bộ Công nghiệp (nay là Bộ Công thương)
Công Nghiệp: Khoa học và Công nghệ (nay là Tạp chí Công thương)
Tạp chí của Bộ Công nghiệp (nay là Bộ Công thương)
Tạp chí Công nghệ Sinh học
Tạp chí của Viện Hàn lâm Khoa học và Công nghệ Việt Nam
Tạp chí Nghiên cứu Con người, Gia đình và Giới
Tạp chí của Viện Nghiên cứu Con người, Gia đình và Giới, Viện Hàn lâm Khoa học xã hội Việt Nam
Tên cũ: Tạp chí Nghiên cứu Con người: https://vjol.in
Tạp chí Nghiên cứu Gia đình và Giới: : https://ifgs.vass.gov.vn/journal/Journal-of-Family-and-Gender-Studies--English-version-.htmlJournal of Human, Family and Gender
Tạp chí của Viện Nghiên cứu Con người, Gia đình và Giới, Viện Hàn lâm Khoa học xã hội Việt Nam
Tên cũ: Tạp chí Nghiên cứu Con người: https://vjol.info.vn/index.php/ihs
Tạp chí Nghiên cứu Gia đình và Giới: https://ifgs.vass.gov.vn/journal/Journal-of-Family-and-Gender-Studies--English-version-.htmlNghiên cứu Con người (nay là Tạp chí Nghiên cứu Con người, Gia đình và Giới)
Tạp chí của Viện Nghiên cứu Con người, Gia đình và Giới, Viện Hàn lâm Khoa học xã hội Việt Nam
Tạp chí Nghiên cứu Lịch sử
Tạp chí của Viện Sử học, Viện Hàn lâm Khoa học xã hội Việt Nam
Tạp chí Nghiên cứu Văn hoá Việt Nam
Tạp chí của Viện Nghiên cứu Văn hoá, Viện Hàn lâm Khoa học xã hội Việt Nam
Tạp chí Nghiên cứu Châu Âu và Châu Mỹ
Tạp chí của Viện Nghiên cứu Châu Âu và Châu Mỹ, Viện Hàn lâm Khoa học xã hội Việt Nam
Journal of European and Americas Studies
Tạp chí của Viện Nghiên cứu Châu Âu và Châu Mỹ, Viện Hàn lâm Khoa học xã hội Việt Nam
Tạp chí Nghiên cứu Á - Phi
Tạp chí của Viện Nghiên cứu Nam Á, Tây Á và Châu Phi
Vietnam Journal of Asian - African Studies
Tạp chí của Viện Nghiên cứu Nam Á, Tây Á và Châu Phi, Viện Hàn lâm Khoa học xã hội Việt Nam
Vietnam Journal of Sociology and Psychology
Tạp chí của Viện Xã hội học và Tâm lý học, Viện Hàn lâm Khoa học xã hội Việt Nam
Tạp chí Xã hội học và Tâm lý học - Xã hội học
Tạp chí của Viện Xã hội học và Tâm lý học, Viện Hàn lâm Khoa học xã hội Việt Nam
Tạp chí Quản lý Kinh tế
Tạp chí của Viện Nghiên cứu Quản lý Kinh tế Trung ương
Tạp chí Triết học
Tạp chí của Viện Triết học - Viện Hàn lâm Khoa học xã hội Việt Nam
Vietnamese journal of philosophy
Tạp chí của Viện Triết học, Viện Hàn lâm Khoa học xã hội Việt Nam
Communications in Physics
Tạp chí của Viện Hàn lâm Khoa học và Công nghệ Việt Nam
Vietnam Journal of Mechanics
Tạp chí của Viện Hàn lâm Khoa học và Công nghệ Việt Nam
Tạp chí Hóa học
Tạp chí của Viện Hàn lâm Khoa học và Công nghệ Việt Nam
Tạp chí Khoa học và Công nghệ các trường đại học kỹ thuật
Tạp chí của Trường Đại học Bách khoa Hà Nội
Tạp chí Khoa học và Công nghệ Đại học Quảng Bình
Tạp chí của Trường Đại học Quảng Bình
Thông tin chi tiết của Tạp chí vui lòng đăng nhập: Tên người dùng: tckhvn Mật khẩu: 123568
-
Tạp chí Sinh lý học Việt Nam
Tạp chí của Hội Sinh lý học Việt Nam
-
Vietnamese Journal of Obstetrics and Gynecology
Tạp chí của Hội Phụ Sản Việt Nam
-
Tạp chí Khoa học và Công nghệ Việt Nam
Bộ Khoa học và Công nghệ
-
Vietnam Journal of Science and Technology - MOST
Bộ Khoa học và Công nghệ
-
Vietnam Journal of Science, Technology and Enginerring (C)
Bộ Khoa học và Công nghệ
-
VMOST Journal of Social Sciences and Humanities (D)
Bộ Khoa học và Công nghệ
-
Tạp chí Giáo dục
Bộ Giáo dục và Đào tạo
-
Vietnam Journal of Education
Bộ Giáo dục và Đào tạo
-
Tạp chí Nông nghiệp và Phát triển nông thôn
Bộ Nông nghiệp và Phát triển nông thôn
-
Journal of Agriculture and Rural Development
Bộ Nông nghiệp và Phát triển nông thôn
-
Tạp chí Tài nguyên và Môi trường
Bộ Tài nguyên và Môi trường
-
Tạp chí Lao động và Xã hội
Bộ Lao động – Thương binh và Xã hội
-
Tạp chí Giao thông vận tải
Bộ Giao thông vận tải
-
Tạp chí Công Thương
Bộ Công Thương
-
Tạp chí Kinh tế và Dự báo
Bộ Kế hoạch và Đầu tư
-
Tạp chí Tài chính
Bộ Tài chính
-
Review of Finance
Bộ Tài chính
-
Tạp chí Dân chủ và Pháp luật
Bộ Tư pháp
-
Tạp chí Quốc phòng toàn dân
Bộ Quốc phòng
-
Tạp chí Xây dựng
Bộ Xây dựng
-
Tạp chí Văn hóa Nghệ thuật
Bộ Văn hóa, Thể thao và Du lịch
-
Tạp chí Y dược học
Bộ Y tế
-
Journal on Information Technologies & Communications
Bộ Thông tin và Truyền thông
-
Chuyên san: Các Công trình Nghiên cứu, Phát triển và Ứng dụng Công nghệ Thông tin và Truyền thông
Bộ Thông tin và Truyền thông
-
Tạp chí Tổ chức nhà nước
Bộ Nội vụ
-
Tạp chí Công an nhân dân
Bộ Công an
-
Tạp chí Ngân hàng
Ngân hàng Nhà nước Việt Nam
-
Tạp chí Khoa học và Công nghệ trong lĩnh vực An toàn thông tin
Ban Cơ yếu Chính phủ
-
Tạp chí Thanh tra
Thanh tra Chính phủ
-
Tạp chí Cộng sản
Ban Chấp hành Trung ương Đảng Cộng sản Việt Nam
-
Tạp chí Công tác Tôn giáo
Ban Tôn giáo Chính phủ
-
Tạp chí Tuyên giáo
Ban Tuyên giáo Trung ương
-
Tạp chí Thanh niên Nghiên cứu khoa học
Trung ương Đoàn Thanh niên Cộng sản Hồ Chí Minh
-
Tạp chí Xây dựng Đảng
Ban Tổ chức Trung ương
-
Tạp chí Bảo hiểm xã hội
Bảo hiểm xã hội Việt Nam
-
Tạp chí Cảnh sát biển Việt Nam
Bộ Tư lệnh Cảnh sát biển Việt Nam
-
Tạp chí Giáo dục nghề nghiệp
Tổng cục Giáo dục nghề nghiệp
-
Tạp chí Khí tượng Thủy văn
Tổng Cục Khí tượng Thủy văn
-
Tạp chí Khoa học Trẻ
Trung tâm Phát triển Khoa học và Công nghệ Trẻ
-
Tạp chí Khoa học và Công nghệ Nhiệt đới
Trung tâm Nhiệt đới Việt - Nga
-
Tạp chí Tiêu chuẩn Đo lường Chất lượng
Tổng cục Tiêu chuẩn Đo lường Chất lượng
-
Tạp chí Nghiên cứu Y dược học cổ truyền Việt Nam
Bệnh viện Y học cổ truyền Trung ương
-
Tạp chí Y dược Thực hành 175
Bệnh viện Quân y 175
-
Tạp chí Y Dược lâm sàng 108
Tạp chí của Viện Nghiên cứu Khoa học Y Dược lâm sàng 108 – Bệnh viện TWQĐ 108
-
Tạp chí Y học lâm sàng Bệnh viện Bạch Mai
Bệnh viện Bạch Mai
-
Y học lâm sàng Bệnh viện Trung ương Huế
Bệnh viện Trung ương Huế
-
Tạp chí Y học Thảm hoạ và Bỏng
Bệnh viện Bỏng quốc gia Lê Hữu Trác
-
Academia Journal of Biology
Viện Sinh học Nhiệt đới, Viện Hàn lâm Khoa học và Công nghệ Việt Nam
-
Acta Mathematica Vietnamica
Viện Toán học, Viện Hàn lâm Khoa học và Công nghệ Việt Nam
-
Advances in Natural Sciences: Nanoscience and Nanotechnology
Viện Hàn lâm Khoa học và Công nghệ Việt Nam
-
Communications in Physics
Viện Vật lý, Viện Hàn lâm Khoa học và Công nghệ Việt Nam
-
Journal of Computer Science and Cybernertics
Viện Công nghệ thông tin, Viện Hàn lâm Khoa học và Công nghệ Việt Nam
-
Vietnam Journal of Earth Sciences
Viện Địa chất, Viện Hàn lâm Khoa học và Công nghệ Việt Nam
-
Vietnam Journal of Biotechnology
Viện Công nghệ Sinh học, Viện Hàn lâm Khoa học và Công nghệ Việt Nam
-
Vietnam Journal of Chemistry
Viện Hóa học, Viện Hàn lâm Khoa học và Công nghệ Việt Nam
-
Vietnam Journal of Marine Science and Technology
Viện Hàn lâm Khoa học và Công nghệ Việt Nam
-
Vietnam Journal of Mathematics
Viện Toán học, Viện Hàn lâm Khoa học và Công nghệ Việt Nam
-
Vietnam Journal of Mechanics
Viện Cơ học, Viện Hàn lâm Khoa học và Công nghệ Việt Nam
-
Vietnam Journal of Science and Technology
Viện Kỹ thuật Nhiệt đới, Viện Hàn lâm Khoa học và Công nghệ Việt Nam
-
Tạp chí Khoa học xã hội Việt Nam
Viện Hàn lâm Khoa học xã hội Việt Nam
-
Vietnam Social Sciences
Viện Hàn lâm Khoa học xã hội Việt Nam
-
Tạp chí Địa lý nhân văn và Phát triển bền vững
Viện Địa lý nhân văn và Phát triển bền vững, Viện Hàn lâm Khoa học xã hội Việt Nam
-
Tạp chí Châu Mỹ Ngày nay
Viện Nghiên cứu Châu Mỹ, Viện Hàn lâm Khoa học xã hội Việt Nam
-
Tạp chí Dân tộc học
Viện Dân tộc học, Viện Hàn lâm Khoa học xã hội Việt Nam
-
Tạp chí Hán Nôm
Viện Nghiên cứu Hán Nôm, Viện Hàn lâm Khoa học xã hội Việt Nam
-
Tạp chí Khoa học xã hội miền Trung
Viện Khoa học xã hội Vùng Trung Bộ, Viện Hàn lâm Khoa học xã hội Việt Nam
-
Tạp chí Khảo cổ học
Viện Khảo cổ học, Viện Hàn lâm Khoa học xã hội Việt Nam
-
Tạp chí Khoa học xã hội Thành phố Hồ Chí Minh
Viện Khoa học xã hội vùng Nam Bộ, Viện Hàn lâm Khoa học xã hội Việt Nam
-
Tạp chí Nghiên cứu Ấn Độ và Châu Á
Viện Nghiên cứu Ấn Độ và Tây Nam Á
-
Tạp chí Nghiên cứu Châu Âu
Viện Nghiên cứu Châu Âu, Viện Hàn lâm Khoa học xã hội Việt Nam
-
Tạp chí Nghiên cứu Đông Bắc Á
Viện Nghiên cứu Đông Bắc Á, Viện Hàn lâm Khoa học xã hội Việt Nam
-
Tạp chí Nghiên cứu Đông Nam Á
Viện Nghiên cứu Đông Nam Á, Viện Hàn lâm Khoa học xã hội Việt Nam
-
Vietnam Journal of Family and Gender Studies
Viện Nghiên cứu Gia đình và Giới, Viện Hàn lâm Khoa học xã hội Việt Nam
-
Tạp chí Nghiên cứu Gia đình và Giới
Viện Nghiên cứu Gia đình và Giới, Viện Hàn lâm Khoa học xã hội Việt Nam
-
Tạp chí Nghiên cứu Lịch sử
Viện Sử học, Viện Hàn lâm Khoa học xã hội Việt Nam
-
Tạp chí Nghiên cứu kinh tế
Tạp chí của Viện Hàn lâm Khoa học xã hội Việt Nam
-
Vietnam’s Socio-Economic development
Viện Kinh tế Việt Nam, Viện Hàn lâm Khoa học xã hội Việt Nam
-
Tạp chí Ngôn ngữ
Viện Ngôn ngữ học, Viện Hàn lâm Khoa học xã hội Việt Nam
-
Tạp chí Nghiên cứu Trung Quốc
Viện Nghiên cứu Trung Quốc
-
Tạp chí Nghiên cứu văn học
Viện Văn học, Viện Hàn lâm Khoa học xã hội Việt Nam
-
Tạp chí Nhà nước và Pháp luật
Viện Nhà nước và Pháp luật, Viện Hàn lâm Khoa học xã hội Việt Nam
-
Tạp chí Những vấn đề Kinh tế và Chính trị thế giới
Viện Kinh tế và Chính trị thế giới, Viện Hàn lâm Khoa học xã hội Việt Nam
-
Vietnam Economic Review
Viện Kinh tế và Chính trị thế giới, Viện Hàn lâm Khoa học xã hội Việt Nam
-
Tạp chí Nghiên cứu Tôn giáo
Viện Nghiên cứu Tôn giáo, Viện Hàn lâm Khoa học xã hội Việt Nam
-
Tạp chí Tâm lý học
Viện Tâm lý học, Viện Hàn lâm Khoa học xã hội Việt Nam
-
Tạp chí Thông tin Khoa học xã hội
Viện Thông tin Khoa học xã hội, Viện Hàn lâm Khoa học xã hội Việt Nam
-
Social Sciences Information Review
Viện Thông tin Khoa học xã hội, Viện Hàn lâm Khoa học xã hội Việt Nam
-
Tạp chí Triết học
Viện Triết học, Viện Hàn lâm Khoa học xã hội Việt Nam
-
Tạp chí Nghiên cứu Con người
Viện Nghiên cứu Con người, Viện Hàn lâm Khoa học xã hội Việt Nam
-
Vietnamese Journal of Philosophy
Viện Triết học, Viện Hàn lâm Khoa học xã hội Việt Nam
-
Tạp chí Từ điển học và Bách khoa thư
Viện Từ điển học và Bách khoa thư Việt Nam
-
Tạp chí Xã hội học Việt Nam
Viện Xã hội học, Viện Hàn lâm Khoa học xã hội Việt Nam
-
Vietnam Journal of Sociology
Viện Xã hội học, Viện Hàn lâm Khoa học xã hội Việt Nam
-
Tạp chí Văn hóa dân gian
Viện Nghiên cứu Văn hóa
-
Tạp chí Bảo vệ thực vật
Viện Bảo vệ thực vật
-
Tạp chí Địa Kỹ thuật
Viện Địa kỹ thuật
-
Tạp chí Dược liệu
Viện Dược liệu
-
Tạp chí Địa chất
Tổng cục Địa chất và Khoáng sản
-
Journal of Geology
Tổng cục Địa chất và Khoáng sản
-
Tạp chí Giáo dục và Xã hội
Viện Nghiên cứu và Ứng dụng công nghệ Giáo dục ATEC
-
Tạp chí Khoa học Biến đổi khí hậu
Viện Khoa học Khí tượng Thủy văn và Biến đổi khí hậu
-
Tạp chí Khoa học Đo đạc và Bản đồ
Viện Khoa học Đo đạc và Bản đồ
-
Tạp chí Khoa học Công nghệ Chăn nuôi
Viện Chăn nuôi
-
Tạp chí Khoa học công nghệ xây dựng
Viện Khoa học công nghệ xây dựng
-
Tạp chí Khoa học Lâm nghiệp
Viện Khoa học Lâm nghiệp Việt Nam
-
Tạp chí Khoa học thể thao
Viện Khoa học Thể dục thể thao
-
Tạp chí Khoa học và Công nghệ Nông nghiệp Việt Nam
Viện Khoa học Nông nghiệp Việt Nam
-
Tạp chí Khoa học và Công nghệ Thủy lợi
Viện Khoa học Thủy lợi Việt Nam
-
Tạp chí Kiểm nghiệm thuốc
Viện Kiểm nghiệm thuốc Trung ương
-
Vietnamese Journal of Food Control
Viện Kiểm nghiệm an toàn vệ sinh thực phẩm quốc gia, Bộ Y tế
-
Tạp chí Kiến trúc Việt Nam
Viện Kiến trúc Quốc gia
-
Tạp chí Kinh tế xây dựng
Viện Kinh tế xây dựng
-
Tạp chí Lãnh đạo và Chính sách
Viện Lãnh đạo học và Chính sách công
-
Tạp chí Môi trường
Viện Chiến lược, Chính sách tài nguyên và môi trường
-
Tạp chí Nghề cá sông Cửu Long
Viện Nghiên cứu Nuôi trồng thủy sản II
-
Tạp chí Nghiên cứu Khoa học và Công nghệ quân sự
Viện Khoa học và Công nghệ quân sự
-
Tạp chí Nghiên cứu Lập pháp
Viện Nghiên cứu lập pháp, Ủy ban Thường vụ Quốc hội
-
Tạp chí Phòng chống bệnh sốt rét và các bệnh ký sinh trùng
Viện Sốt rét - Ký sinh trùng - Côn trùng Trung ương
-
Tạp chí Quy hoạch xây dựng
Viện Quy hoạch đô thị và nông thôn quốc gia, Bộ Xây dựng
-
Tạp chí Văn hóa học
Viện Văn hóa Nghệ thuật quốc gia Việt Nam
-
Tạp chí Vật liệu và Xây dựng
Viện Vật liệu Xây dựng
-
Journal of Materials and Construction
Viện Vật liệu Xây dựng
-
Tạp chí Việt Nam hội nhập
Viện Chính sách, Pháp luật và Quản lý
-
Tạp chí Y dược học cổ truyền Quân sự
Viện Y học cổ truyền Quân đội
-
Tạp chí Nghiên cứu và Phát triển
Viện Nghiên cứu Phát triển Thừa Thiên Huế
-
Tạp chí Y học Cộng đồng
Viện Sức khỏe Cộng đồng
-
Tạp chí Y học Quân sự
Viện Y học Dự phòng Quân đội
-
Tạp chí Khoa học Đại học Quốc gia Hà Nội: Các Khoa học Trái đất và Môi trường
Đại học Quốc gia Hà Nội
-
Tạp chí Khoa học Đại học Quốc gia Hà Nội: Công nghệ Thông tin - Truyền thông
Đại học Quốc gia Hà Nội
-
Tạp chí Khoa học Đại học Quốc gia Hà Nội: Khoa học Tự nhiên và Công nghệ
Đại học Quốc gia Hà Nội
-
Tạp chí Khoa học Đại học Quốc gia Hà Nội: Khoa học Y Dược
Đại học Quốc gia Hà Nội
-
Tạp chí Khoa học Đại học Quốc gia Hà Nội: Luật học
Đại học Quốc gia Hà Nội
-
Tạp chí Khoa học Đại học Quốc gia Hà Nội: Nghiên cứu Chính sách và Quản lý
Đại học Quốc gia Hà Nội
-
Tạp chí Khoa học Đại học Quốc gia Hà Nội: Nghiên cứu Giáo dục
Đại học Quốc gia Hà Nội
-
Tạp chí Khoa học Đại học Quốc gia Hà Nội: Toán - Lý
Đại học Quốc gia Hà Nội
-
Journal of Science: Advanced Materials and Devices
Đại học Quốc gia Hà Nội
-
Tạp chí Phát triển Khoa học và Công nghệ - Khoa học Sức khoẻ
Đại học Quốc gia Thành phố Hồ Chí Minh
-
Tạp chí Phát triển Khoa học và Công nghệ - Khoa học Trái đất và Môi trường
Đại học Quốc gia Thành phố Hồ Chí Minh
-
Tạp chí Phát triển Khoa học và Công nghệ - Khoa học Tự nhiên
Đại học Quốc gia Thành phố Hồ Chí Minh
-
Tạp chí Phát triển Khoa học và Công nghệ - Khoa học Xã hội và Nhân văn
Đại học Quốc gia Thành phố Hồ Chí Minh
-
Tạp chí Phát triển Khoa học và Công nghệ - Kinh tế-Luật và Quản lý
Đại học Quốc gia Thành phố Hồ Chí Minh
-
Science and Technology Development Journal
Đại học Quốc gia Thành phố Hồ Chí Minh
-
Tạp chí Phát triển Khoa học và Công nghệ - Kỹ thuật và Công nghệ
Đại học Quốc gia Thành phố Hồ Chí Minh
-
Tạp chí Khoa học Đại học Huế: Khoa học Tự nhiên
Đại học Huế
-
Tạp chí Khoa học và Công nghệ
Đại học Đà Nẵng
-
Tạp chí Khoa học và Công nghệ - Đại học Thái Nguyên
Đại học Thái Nguyên
-
Tạp chí Khoa học Công nghệ Xây dựng
Trường Đại học Xây dựng Hà Nội
-
Journal of Science and Technology in Civil Engineering
Trường Đại học Xây dựng Hà Nội
-
Tạp chí Giáo dục Nghệ thuật
Trường Đại học Sư phạm Nghệ thuật Trung ương
-
Journal of Medical and Pharmaceutical Research - MEDPHARMRES
Đại học Y Dược Thành phố Hồ Chí Minh
-
Journal of Technology & Innovation - JTIN
Trường Đại học Công nghệ Thành phố Hồ Chí Minh (HUTECH)
-
Tạp chí Khoa học Chính trị quân sự
Trường Đại học Chính trị
-
Tạp chí Khoa học Giáo dục Kỹ thuật
Trường Đại học Sư phạm Kỹ thuật Thành phố Hồ Chí Minh
-
Journal of Technical Education Science
Trường Đại học Sư phạm Kỹ thuật Thành phố Hồ Chí Minh
-
Tạp chí Khoa học Lạc Hồng
Trường Đại học Lạc Hồng
-
Tạp chí Khoa học Điều dưỡng
Trường Đại học Điều dưỡng Nam Định
-
Tạp chí Khoa học Lạc Hồng: Chuyên san Kỹ thuật
Trường Đại học Lạc Hồng
-
Tạp chí Khoa học Sức khoẻ
Trường Đại học Y Dược Hải Phòng
-
Journal of Health Sciences
Trường Đại học Y Dược Hải Phòng
-
Tạp chí Khoa học – Công nghệ thủy sản
Trường Đại học Nha Trang
-
Tạp chí Khoa học Đại học Sài Gòn
Trường Đại học Sài Gòn
-
Tạp chí Khoa học Đại học Cần Thơ
Trường Đại học Cần Thơ
-
CTU Journal of Innovation and Sustainable Development
Trường Đại học Cần Thơ
-
Tạp chí Khoa học Đại học Cửu Long
Trường đại học Cửu Long
-
Tạp chí Khoa học Đại học Đà Lạt
Trường Đại học Đà Lạt
-
Tạp chí Khoa học Đại học Đồng Tháp
Trường Đại học Đồng Tháp
-
Dong Thap University Journal of Science
Trường Đại học Đồng Tháp
-
Tạp chí Khoa học Đại học Hạ Long
Trường Đại học Hạ Long
-
Tạp chí Khoa học Đại học Hà Tĩnh
Trường Đại học Hà Tĩnh
-
Tạp chí Khoa học Đại học Hải Phòng
Trường Đại học Hải Phòng
-
Tạp chí Khoa học Đào tạo và Huấn luyện thể thao
Trường Đại học Thể dục thể thao Bắc Ninh
-
Tạp chí Khoa học Đại học Đồng Nai
Trường Đại học Đồng Nai
-
Tạp chí Khoa học Trường Đại học Hoa Sen
Trường Đại học Hoa Sen
-
Tạp chí Khoa học Trường Đại học Hồng Đức
Trường Đại học Hồng Đức
-
Hong Duc University Journal of Science
Trường Đại học Hồng Đức
-
Tạp chí Khoa học Đại học Khánh Hoà
Trường Đại học Khánh Hoà
-
Tạp chí Khoa học Trường Đại học Bà Rịa - Vũng Tàu
Trường Đại học Bà Rịa – Vũng Tàu
-
Tạp chí Khoa học Trường Đại học Bạc Liêu
Trường Đại học Bạc Liêu
-
Tạp chí Khoa học Trường Đại học Mở Hà Nội
Trường Đại học Mở Hà Nội
-
Ho Chi Minh City Open University Journal of Science - Economics and Business Administration
Trường Đại học Mở Thành phố Hồ Chí Minh
-
Tạp chí Khoa học Đại học Mở Thành phố Hồ Chí Minh - Kinh tế và Quản trị kinh doanh
Trường Đại học Mở Thành phố Hồ Chí Minh
-
Tạp chí Khoa học Đại học Mở Thành phố Hồ Chí Minh – Kỹ thuật và Công nghệ
Trường Đại học Mở Thành phố Hồ Chí Minh
-
Tạp chí Khoa học Đại học Mở Thành phố Hồ Chí Minh – Khoa học Xã hội
Trường Đại học Mở Thành phố Hồ Chí Minh
-
Ho Chi Minh City Open University Journal of Science - Social Sciences
Trường Đại học Mở Thành phố Hồ Chí Minh
-
Tạp chí Khoa học Trường Đại học Ngoại ngữ - Tin học Thành phố Hồ Chí Minh
Trường Đại học Ngoại ngữ - Tin học Thành phố Hồ Chí Minh
-
Tạp chí Khoa học Trường Đại học Phú Yên
Trường Đại học Phú Yên
-
Tạp chí Khoa học Trường Đại học Quảng Nam
Trường Đại học Quảng Nam
-
Hong Bang International University Journal of science
Trường Đại học Quốc tế Hồng Bàng
-
Ho Chi Minh City Open University Journal of Science - Engineering and Technology
Trường Đại học Mở Thành phố Hồ Chí Minh
-
Hong Bang International University Journal of science
Trường Đại học Quốc tế Hồng Bàng
-
Tạp chí Khoa học Trường Đại học Quy Nhơn
Trường Đại học Quy Nhơn
-
Tạp chí Khoa học Trường Đại học Sư phạm Hà Nội: Khoa học Giáo dục
Trường Đại học Sư phạm Hà Nội
-
Tạp chí Khoa học Trường Đại học Sư phạm Hà Nội: Khoa học Tự nhiên
Trường Đại học Sư phạm Hà Nội
-
Tạp chí Khoa học Trường Đại học Sư phạm Hà Nội: Khoa học Xã hội
Trường Đại học Sư phạm Hà Nội
-
Tạp chí Khoa học Trường Đại học Sư phạm Hà Nội 2: Chuyên san Khoa học Giáo dục
Trường Đại học Sư phạm Hà Nội 2
-
Tạp chí Khoa học Trường Đại học Sư phạm Hà Nội 2: Chuyên san Khoa học Tự nhiên và Công nghệ
Trường Đại học Sư phạm Hà Nội 2
-
Tạp chí Khoa học Trường Đại học Sư phạm Hà Nội 2: Chuyên san Khoa học Xã hội và Nhân văn
Trường Đại học Sư phạm Hà Nội 2
-
Tạp chí Khoa học, Trường Đại học Sư phạm, Đại học Huế
Trường Đại học Sư phạm, Đại học Huế
-
Tạp chí Khoa học Đại học Tân Trào
Trường Đại học Tân Trào
-
Tạp chí khoa học – Trường đại học Tây Bắc
Trường Đại học Tây Bắc
-
Tạp chí Khoa học Đại học Thủ Dầu Một
Trường Đại học Thủ Dầu Một
-
Tạp chí Khoa học – Trường Đại học Thủ đô Hà Nội: Khoa học Tự nhiên và Công nghệ
Trường Đại học Thủ đô Hà Nội
-
Tạp chí Khoa học – Trường Đại học Thủ đô Hà Nội: Khoa học Xã hội và Giáo dục
Trường Đại học Thủ đô Hà Nội
-
Tạp chí Khoa học Trường Đại học Trà Vinh
Trường Đại học Trà Vinh
-
Tạp chí khoa học Đại học Văn Hiến
Trường Đại học Văn Hiến
-
Tạp chí Khoa học Đại học Văn Lang
Trường Đại học Văn Lang
-
Tạp chí Khoa học Trường Đại học Vinh
Trường Đại học Vinh
-
Tạp chí Khoa học Yersin
Trường Đại học Yersin Đà Lạt
-
Tạp chí Khoa học Giao thông vận tải
Trường Đại học Giao thông vận tải
-
Transport and Communications Science Journal
Trường Đại học Giao thông vận tải
-
Tạp chí Khoa học Kiểm sát
Trường Đại học Kiểm sát Hà Nội
-
Tạp chí Khoa học Kiến trúc & Xây dựng
Trường Đại học Kiến trúc Hà Nội
-
Tạp chí Khoa học Kinh tế
Trường Đại học Kinh tế - Đại học Đà Nẵng
-
Tạp chí Khoa học Kỹ thuật Mỏ - Địa chất
Trường Đại học Mỏ - Địa chất
-
Tạp chí Khoa học kỹ thuật Thủy lợi và Môi trường
Trường Đại học Thủy lợi
-
Tạp chí Khoa học Nghiên cứu Sức khỏe và Phát triển
Trường Đại học Y tế công cộng
-
Tạp chí Khoa học Ngoại ngữ
Trường Đại học Hà Nội
-
Tạp chí Khoa học Ngôn ngữ và Văn hóa
Trường Đại học Ngoại ngữ, Đại học Huế
-
Tạp chí Khoa học Tây Nguyên
Trường Đại học Tây Nguyên
-
Tạp chí Khoa học quốc tế AGU
Trường Đại học An Giang, Đại học Quốc Gia Hồ Chí Minh
-
Tạp chí Khoa học Thương mại
Trường Đại học Thương mại
-
Tạp chí Khoa học Trường Đại học Sư phạm Thành phố Hồ Chí Minh
Trường Đại học Sư phạm Thành phố Hồ Chí Minh
-
JST: Engineering and Technology for Sustainable Development
Các trường đại học kỹ thuật - Đại học Bách khoa Hà Nội
-
Smart Systems and Devices (SSAD)
Tạp chí của Đại học Bách khoa Hà Nội
-
Tạp chí Khoa học Pháp lý
Trường Đại học Luật Thành phố Hồ Chí Minh
-
Tạp chí Khoa học và Công nghệ
Trường Đại học Hùng Vương
-
Tạp chí Khoa học và Công nghệ
Trường Đại học Công nghiệp Hà Nội
-
Tạp chí Khoa học và Công nghệ
Trường Đại học Khoa học, Đại học Huế
-
Tạp chí Khoa học và Công nghệ Cần Thơ
Trường Đại học Kỹ thuật - Công nghệ Cần Thơ
-
Tạp chí Khoa học và Công nghệ - Trường Đại học Bình Dương
Trường Đại học Bình Dương
-
Tạp chí Khoa học và Công nghệ - Trường Đại học Công nghiệp Thành phố Hồ Chí Minh
Trường Đại học Công nghiệp Thành phố Hồ Chí Minh
-
Tạp chí Khoa học & Công nghệ Đại học Duy Tân
Trường Đại học Duy Tân
-
Tạp chí Khoa học và Công nghệ Trường Đại học Hòa Bình
Trường Đại học Hòa Bình
-
Tạp chí Khoa học và Công nghệ Trường Đại học Kinh tế - Kỹ thuật Công nghiệp
Trường Đại học Kinh tế - Kỹ thuật Công nghiệp
-
Tạp chí Khoa học và Công nghệ - Đại học Nguyễn Tất Thành
Trường Đại học Nguyễn Tất Thành
-
Tạp chí Khoa học và Công nghệ Trường Đại học Phạm Văn Đồng
Trường Đại học Phạm Văn Đồng
-
Tạp chí Khoa học và Công Nghệ Trường Đại học Xây dựng Miền Tây
Trường Đại học Xây dựng Miền Tây
-
Tạp chí Khoa học Công nghệ Hàng hải
Trường Đại học Hàng hải Việt Nam
-
Tạp chí Khoa học Tài nguyên và Môi trường
Trường Đại học Tài nguyên và Môi trường Hà Nội
-
Tạp chí Khoa học và Công nghệ Lâm nghiệp
Trường Đại học Lâm nghiệp
-
Journal of Forestry Science and Technology
Trường Đại học Lâm nghiệp
-
Tạp chí Khoa học và Công nghệ Năng lượng
Trường Đại học Điện lực
-
Tạp chí Khoa học và Công nghệ Nông nghiệp
Trường Đại học Nông Lâm, Đại học Huế
-
Tạp chí Khoa học Công nghệ và Thực phẩm
Trường Đại học Công nghiệp Thực phẩm Thành phố Hồ Chí Minh
-
Tạp chí Khoa học và Đào tạo thể thao
Trường Đại học Thể dục Thể thao Đà Nẵng
-
Tạp chí Khoa học và Kỹ thuật
Đại học Kỹ thuật Lê Quý Đôn
-
Journal of Science and Technique - Section on Information and Communication Technology (JST-ICT)
Đại học Kỹ thuật Lê Quý Đôn
-
Journal of Science and Technique - Section on Physics and Chemical Engineering (JST-PCE)
Đại học Kỹ thuật Lê Quý Đôn
-
Journal of Science and Technique - Section on Special Construction Engineering (JST-SCE)
Đại học Kỹ thuật Lê Quý Đôn
-
Tạp chí Khoa học Xã hội, Nhân văn và Giáo dục
Trường Đại học Sư phạm – Đại học Đà Nẵng
-
Tạp chí Khoa học Xã hội và Nhân văn
Trường Đại học Khoa học Xã hội và Nhân văn
-
Tạp chí Kinh doanh và Công nghệ
Trường Đại học Kinh doanh và Công nghệ Hà Nội
-
Tạp chí Kinh tế và Kinh doanh
Trường Đại học Kinh tế - Đại học Quốc gia Hà Nội
-
Tạp chí Kinh tế và Ngân hàng châu Á
Trường Đại học Ngân hàng Thành phố Hồ Chí Minh
-
Asian Journal of Economics and Banking
Trường Đại học Ngân hàng Thành phố Hồ Chí Minh
-
Tạp chí Kinh tế và Phát triển
Trường Đại học Kinh tế Quốc dân
-
Journal of Economics and Development
Trường Đại học Kinh tế Quốc dân
-
Tạp chí Luật học
Trường Đại học Luật Hà Nội
-
Tạp chí Nghiên cứu dược và Thông tin thuốc
Trường Đại học Dược Hà Nội
-
Tạp chí Nghiên cứu khoa học - Đại học Sao Đỏ
Trường Đại học Sao Đỏ
-
Tạp chí Nghiên cứu Khoa học và Phát triển
Trường Đại học Thành Đô
-
Tạp chí Nghiên cứu khoa học và Phát triển kinh tế
Trường Đại học Tây Đô
-
Tạp chí Nghiên cứu Kinh tế và Kinh doanh Châu Á
Trường Đại học Kinh tế TP. Hồ Chí Minh
-
Journal Of Asian Business And Economic Studies
Trường Đại học Kinh tế TP. Hồ Chí Minh
-
Tạp chí Nghiên cứu nước ngoài
Trường Đại học Ngoại ngữ, Đại học Quốc gia Hà Nội
-
Tạp chí Nghiên cứu Tài chính – Marketing
Trường Đại học Tài chính – Marketing
-
Tạp chí Nghiên cứu Văn hóa
Trường Đại học Văn hóa Hà Nội
-
Tạp chí Nghiên cứu Y học
Trường Đại học Y Hà Nội, Bộ Y tế
-
Tạp chí Nông nghiệp và Phát triển
Trường Đại học Nông Lâm Thành phố Hồ Chí Minh
-
The Journal of Agriculture and Development
Trường Đại học Nông Lâm Thành phố Hồ Chí Minh
-
Tạp chí Pháp luật và Thực tiễn
Trường Đại học Luật, Đại học Huế
-
Tạp chí Phát triển và Hội nhập
Trường Đại học Kinh tế - Tài chính Thành phố Hồ Chí Minh
-
Tạp chí Phòng cháy và chữa cháy
Trường Đại học Phòng cháy và chữa cháy – Bộ Công an
-
Tạp chí Quản lý và Kinh tế quốc tế
Trường Đại học Ngoại thương
-
Journal of International Economics and Management
Trường Đại học Ngoại thương
-
Tạp chí Văn hóa và Nguồn lực
Trường Đại học Văn hóa Thành phố Hồ Chí Minh
-
Tạp chí Y Dược học Cần Thơ
Trường Đại học Y Dược Cần Thơ
-
Tạp chí Y Dược Huế
Trường Đại học Y – Dược, Đại học Huế
-
Tạp chí Y Dược học Phạm Ngọc Thạch
Trường Đại học Y khoa Phạm Ngọc Thạch
-
Tạp chí Y Dược Thái Bình
Trường Đại học Y Dược Thái Bình
-
Journal of Advanced Engineering and Computation
Trường Đại học Tôn Đức Thắng
-
Tạp chí điện tử Khoa học và Công nghệ QUI
Trường Đại học Công nghiệp Quảng Ninh
-
Tạp chí Chính sách và Quản lý Khoa học và Công nghệ
Học viện Khoa học, Công nghệ và Đổi mới sáng tạo
-
Tạp chí Chủ nghĩa xã hội – Lý luận và Thực tiễn
Viện Chủ nghĩa xã hội khoa học – Học viện Chính trị quốc gia Hồ Chí Minh
-
Tạp chí Giáo dục lý luận
Học viện Chính trị khu vực I
-
Tạp chí Khoa học chính trị
Học viện Chính trị khu vực II
-
Tạp chí Kinh tế và Quản lý
Học viện Chính trị quốc gia Hồ Chí Minh
-
Tạp chí Lịch sử Đảng
Viện Lịch sử Đảng – Học viện Chính trị quốc gia Hồ Chí Minh
-
Journal of Vietnam Communist Party's History
Viện Lịch sử Đảng – Học viện Chính trị quốc gia Hồ Chí Minh
-
Tạp chí Lý luận chính trị
Học viện Chính trị quốc gia Hồ Chí Minh
-
Political Theory
Học viện Chính trị quốc gia Hồ Chí Minh
-
Tạp chí Nghiên cứu Hồ Chí Minh
Viện Hồ Chí Minh và các lãnh tụ của Đảng, Học viện Chính trị quốc gia Hồ Chí Minh
-
Tạp chí Pháp luật về quyền con người
Viện Quyền con người - Học viện Chính trị quốc gia Hồ Chí Minh
-
Tạp chí Sinh hoạt lý luận
Học viện Chính trị khu vực III
-
Tạp chí Lý luận chính trị và Truyền thông
Học viện Báo chí và Tuyên truyền
-
Tạp chí Thông tin Khoa học Chính trị
Học viện Chính trị khu vực IV
-
Tạp chí Thông tin khoa học lý luận chính trị
Học viện Chính trị quốc gia Hồ Chí Minh
-
Tạp chí Triết học và Đời sống
Viện Triết học, Học viện Chính trị quốc gia Hồ Chí Minh
-
Tạp chí Cảnh sát nhân dân
Học viện Cảnh sát nhân dân
-
Tạp Chí Khoa Học Công Nghệ Hàng Không
Học viện Hàng không Việt Nam
-
Tạp chí Khoa học Công nghệ Thông tin và Truyền thông
Học viện Công nghệ Bưu chính Viễn thông
-
Tạp chí Khoa học và Đào tạo Ngân hàng
Học viện Ngân hàng
-
Journal of Economic and Banking Studies
Học viện Ngân hàng
-
Tạp chí Khoa học giáo dục Biên phòng
Học viện Biên phòng
-
Tạp chí Khoa học giáo dục Phòng không - Không quân
Học viện Phòng không - Không quân
-
Tạp chí Khoa học Học viện Phụ nữ Việt Nam
Học viện Phụ nữ Việt Nam
-
Tạp chí Khoa học Ngoại ngữ Quân sự
Học viện Khoa học Quân sự
-
Tạp chí Khoa học Nông nghiệp Việt Nam
Học viện Nông nghiệp Việt Nam
-
Vietnam Journal of Agricultural Sciences
Học viện Nông nghiệp Việt Nam
-
Tạp chí Khoa học Phát triển nhân lực
Học viện Cán bộ Thành phố Hồ Chí Minh
-
Tạp chí Khoa học Quản lý giáo dục
Trường Cán bộ quản lý giáo dục Thành phố Hồ Chí Minh - Bộ Giáo dục và Đào tạo
-
Tạp chí Nghề luật
Học viện Tư pháp – Bộ Tư pháp
-
Tạp chí Nghiên cứu Dân tộc
Học viện Dân tộc
-
Tạp chí Nghiên cứu Quốc tế
Học viện Ngoại giao, Bộ Ngoại giao
-
Journal of international studies
Học viện Ngoại giao, Bộ Ngoại giao
-
Tạp chí Nghiên cứu Chiến thuật - Chiến dịch
Học viện Lục quân
-
Tạp chí Nghiên cứu Tài chính kế toán
Học viện Tài chính
-
Journal of Finance and Accounting Research
Học viện Tài chính
-
Tạp chí Nhân lực khoa học xã hội
Học viện Khoa học xã hội, Viện Hàn lâm Khoa học xã hội Việt Nam
-
Tạp chí Quản lý giáo dục
Học viện Quản lý giáo dục
-
Tapj chis Quản lý nhà nước
Học viện Hành chính Quốc gia
-
State Management Review
Học viện Hành chính Quốc gia
-
Tạp chí Xây dựng và Đô thị
Học viện Cán bộ quản lý xây dựng và đô thị
-
Tạp chí Y Dược cổ truyền Việt Nam
Học viện Y Dược học cổ truyền Việt Nam
-
Tạp chí Y Dược học Quân sự
Học viện Quân y
-
Tạp chí Ánh sáng và Cuộc sống
Hội Chiếu sáng Việt Nam
-
Tạp chí Cấp Thoát nước Việt Nam
Hội Cấp thoát nước Việt Nam
-
Tạp chí Cầu đường Việt Nam
Hội Khoa học kỹ thuật cầu đường Việt Nam
-
Tạp chí Công nghiệp Nông thôn
Hội Cơ khí Nông nghiệp Việt Nam
-
Tạp chí Cơ khí Việt Nam
Tổng Hội cơ khí Việt Nam
-
Tạp chí Công nghiệp Mỏ
Hội Khoa học và Công nghệ Mỏ Việt Nam
-
Tạp chí Da liễu học Việt Nam
Hội Da liễu Việt Nam, Tổng hội Y học Việt Nam
-
Tạp chí Dân tộc & Thời đại
Hội Dân tộc học và Nhân học Việt Nam
-
Tạp chí Dầu khí
Tập đoàn Dầu khí Việt Nam
-
Tạp chí Điện quang và Y học hạt nhân Việt Nam
Hội Điện quang và Y học hạt nhân Việt Nam
-
Tạp chí Điện Việt Nam
Hiệp hội Công nghiệp kỹ thuật Điện Việt Nam
-
Tạp chí Dinh dưỡng và Thực Phẩm
Hội Dinh dưỡng Việt Nam
-
Tạp chí Điều dưỡng Việt Nam
Hội Điều dưỡng Việt Nam
-
Tạp chí Gan mật Việt Nam
Hội Gan mật Việt Nam
-
Tạp chí Giáo chức Việt Nam
Hội Cựu Giáo chức Việt Nam
-
Tạp chí Hoá Học và Ứng dụng
Hội Hoá học Việt Nam
-
Tạp chí Kết cấu và Công nghệ xây dựng
Hội Kết cấu và Công nghệ xây dựng Việt Nam
-
Tạp chí Kế toán và Kiểm toán
Hiệp hội Kế toán và Kiểm toán Việt Nam
-
Tạp chí Khoa học – Công nghệ Kim loại
Hội Khoa học – Kỹ thuật Đúc – Luyện kim Việt Nam
-
Tạp chí Khoa học kỹ thuật Chăn nuôi
Hội Chăn nuôi Việt Nam
-
Tạp chí Khoa học kỹ thuật Thú y
Hội Thú y Việt Nam
-
Tạp chí Khoa học Đất
Hội Khoa học Đất Việt Nam
-
Tạp chí Khoa học Phát triển Nông thôn Việt Nam
Hội Khoa học Phát triển Nông thôn Việt Nam
-
Tạp chí Khoa học Tiêu hóa Việt Nam
Hội Khoa học Tiêu hóa Việt Nam
-
Tạp chí Kiến trúc
Hội Kiến trúc sư Việt Nam
-
Tạp chí Lao và Bệnh phổi
Hội Phổi Việt Nam
-
Tạp chí Luật sư Việt Nam
Liên đoàn Luật sư Việt Nam
-
Tạp chí Lý luận, phê bình văn học, nghệ thuật
Hội đồng Lý luận, phê bình văn học, nghệ thuật Trung ương
-
Tạp chí Môi trường và Đô thị Việt Nam
Hiệp hội Môi trường, Đô thị và Khu công nghiệp Việt Nam
-
Tạp chí Năng lượng Nhiệt
Tạp chí khoa học của Hội Khoa học Kỹ thuật Nhiệt Việt Nam
-
Tạp chí Ngoại khoa và Phẫu thuật nội soi Việt Nam
Hội Ngoại khoa và Phẫu thuật nội soi Việt Nam
-
Tạp chí Ngôn ngữ & đời sống
Hội Ngôn ngữ học Việt Nam
-
Tạp chí Người Xây dựng
Tổng hội Xây dựng Việt Nam
-
Tạp chí Nhãn khoa Việt Nam
Hội Nhãn khoa Việt Nam
-
Tạp chí Nhi khoa
Hội Nhi khoa Việt Nam
-
Tạp chí Người Làm Báo
Hội Nhà báo Việt Nam
-
Tạp chí Nội tiết- Đái tháo đường Việt Nam
Hội Nội tiết-Đái tháo đường Việt Nam
-
Tạp chí Nông thôn mới
Trung ương Hội Nông dân Việt Nam
-
Tạp chí "Nuclear Science and Technology"
Hội Năng lượng nguyên tử Việt Nam
-
Tạp chí Phân tích Hóa, Lý và Sinh học
Hội Khoa học Kỹ thuật Phân tích Hóa, Lý và Sinh học Việt Nam
-
Tạp chí Pháp luật và Phát triển
Hội Luật gia Việt Nam
-
Tạp chí Phẫu thuật Tim mạch và Lồng ngực Việt Nam
Hội Phẫu thuật Tim mạch và Lông ngực Việt Nam
-
Tạp chí Phụ Sản
Hội Phụ Sản Việt Nam
-
Tạp chí Quy hoạch Đô thị
Hội Quy hoạch phát triển đô thị Việt Nam
-
REV Journal on Electronics and Communications
Hội Vô tuyến Điện tử Việt Nam
-
Tạp chí Sinh lý học Việt Nam
Hội Sinh lý học Việt Nam
-
Tạp chí Tài chính doanh nghiệp
Hội Tư vấn thuế Việt Nam
-
Tạp chí Tai Mũi Họng
Hội Tai Mũi Họng Việt Nam
-
Tạp chí Tài nguyên nước
Hội Thủy lợi Việt Nam
-
Tạp chí Tâm lý học Việt Nam
Hội Tâm lý học Việt Nam
-
Tạp chí Thần kinh học Việt Nam
Hội Thần kinh học Việt Nam
-
Tạp chí Thế giới Di sản
Hội Di sản Văn hóa Việt Nam
-
Tạp chí Thế giới trong ta
Hội Khoa học Tâm lý giáo dục Việt Nam
-
Tạp chí Thị trường Tài chính Tiền tệ
Hiệp hội Ngân hàng Việt Nam
-
Tạp chí Thiết bị Giáo dục
Hiệp Hội Thiết bị Giáo dục Việt Nam
-
Tạp chí Tim mạch học Việt Nam
Hội Tim mạch học Việt Nam
-
Tạp chí Thuốc và Sức Khỏe
Hội Dược học Việt Nam
-
Tạp chí Truyền nhiễm Việt Nam
Hội Truyền nhiễm Việt Nam
-
Tạp chí Tự động hóa ngày nay
Hội Tự động hóa Việt Nam
-
Tạp chí Ung thư học Việt Nam
Hội Ung thư Việt Nam
-
Tạp chí Văn hóa Phật giáo
Giáo hội Phật giáo Việt Nam
-
Tạp chí Văn học nước ngoài
Hội Nhà văn Việt Nam
-
Tạp chí Xúc tác và Hấp phụ Việt Nam
Hội Khoa học Công nghệ Xúc tác và Hấp phụ Việt Nam
-
Tạp chí Y học dự phòng
Hội Y học dự phòng Việt Nam
-
Tạp chí Y học Việt Nam
Tổng hội Y học Việt Nam
-
Tạp chí Y tế Công cộng
Hội Y tế Công cộng Việt Nam (VPHA)
-
Tạp chí Nghiên cứu Địa lý nhân văn
Viện Địa lí nhân văn - Viện Hàn lâm Khoa học Xã hội Việt Nam

Tạp chí của Hội Chăn nuôi Việt Nam
Tạp chí của Hội Chăn nuôi Việt Nam
























































































































































































































































































































































































































































































































































